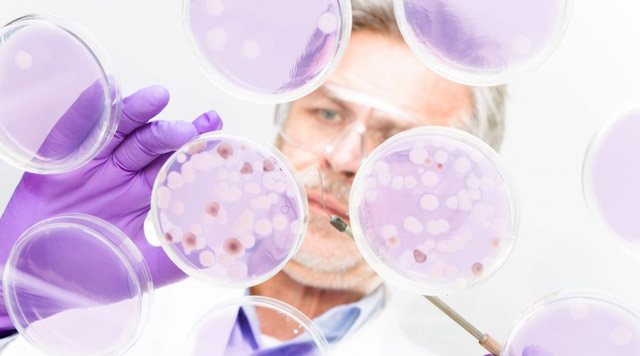
image

Иерсиниоз — острая кишечная инфекция, отличающаяся многоочаговостью: поражением кишечника, костей и суставов, печени, почек, лимфоузлов и миокарда. Это антропозооноз, характеризующийся передачей возбудителя от животных к человеку и сопровождающийся токсико-аллергической реакцией.
Поскольку при иерсиниозе поражаются различные внутренние органы, его клинические проявления весьма разнообразны. Из-за такого многообразия симптомов возникают определенные трудности в диагностике заболевания. В этом заключается опасность данного недуга, который часто осложняется другими патологиями, представляющими угрозу для жизни больных.
Иерсиниоз возникает у лиц любого возраста, но чаще всего он поражает организм маленьких детей. У больных появляются признаки интоксикационного синдрома, пятнисто-папулезная сыпь, диспепсические явления, гепатоспленомегалия, артропатия, боль в животе. Диагностика патологии основывается на результатах микробиологического исследования биологического материала, в котором обнаруживают иерсинии — возбудители патологии.
Мужчины в наибольшей степени подвержены иерсиниозу, чем женщины. Болезнь распространена повсеместно, но чаще встречается в регионах с умеренным климатом. Обычно возникают спорадические случаи инфекции, но возможны и вспышки. Заболеваемость достигает максимума в зимне-весенний период, что связано с повышением биологической активности грызунов в это время года.
Общие сведения
Термин «иерсиниозы/иерсиниозная инфекция» объединяет два инфекционных заболевания — псевдотуберкулез и иерсиниоз, которые вызываются бактериями Enterobacteriaceae рода Yersinia: иерсиниоз — патогенными Y. Еnterocolitica, а псевдотуберкулез — Y. Pseudotuberculosis. Проявляются интоксикационно-воспалительным синдромом, поражением желудочно-кишечного тракта, печени, суставов, а при генерализованных и смешанных формах – полиорганными поражениями. Присутствует склонность к хроническому течению. Из известных науке 11 видов иерсиний, три являются возбудителями заболеваний человека: кишечные патогены (Yersinia enterocolitica и Yersinia pseudotuberculosis) и Yersinia pestis (возбудитель чумы). Несмотря на то, что возбудители иерсиниоза и псевдотуберкулеза относятся к разным видам, у них много общего, в частности в плане диагностики и клинической картины. Важность и значимость иерсиниозов обусловлены их принадлежностью к так называемым эмерджентным (возвращающимся) инфекциям, одновременно с чумной инфекцией.
Опасность возникновения и непредсказуемость иерсиниозов требуют усиленного контроля, особенно в свете того, что эти возбудители признаны потенциальными агентами биотерроризма. Большую опасность представляет и потенциальная способность популяций патогенных иерсиний к реверсии вирулентных свойств, что обусловлено возможностью изменений в их геноме при попадании в определенные условия внешней среды. Установлено, что возбудитель чумы (Y. Pestis) может эволюционировать из возбудителя псевдотуберкулеза и оба патогена почти генетически идентичны.
Уровень ежегодной официально регистрируемой заболеваемости иерсиниозами не высок (рис. выше) и фиксируется преимущественно в виде спорадической (2-15 случаев/100 тыс. населения), реже — вспышечной заболеваемости, однако, истинную ситуацию эти показатели не отражают, причиной чего является гиподиагностика инфекции, обусловленная полиморфизмом клинических проявлений, приводящая к постановке ошибочных диагнозов. В некоторых регионах РФ (Сибирский регион, Дальний Восток, Северо-Запад) показатели заболеваемости значительно выше и превосходят средние показатели по стране в 2-3 раза (9,75-24,45/100 тыс. населения).
Поражаются все возрастные группы, при этом, заболеваемость среди детей в 3-4 раза выше, чем у взрослых. Характерна зимне-весенняя сезонность.
Лабораторная диагностика
Заподозрить иерсиниоз может терапевт или врач скорой помощи, но окончательный «вердикт» выносит инфекционист. Для этого ему понадобятся данные клинических, лабораторных и инструментальных исследований. Для постановки диагноза в первую очередь проводится бактериологическое исследование. Биологический материал, который берется у человека, высеивают на специальных питательных средах.
В качестве биоматериала может быть моча, кал, мокрота, посев из зева. Параллельно с этим назначаются и другие анализы, так как сама диагностика занимает около двух недель. Кроме того, применяется серологический метод для выявления антител в крови. Проводится реакция пассивной гемагглютинации (РПГА). У пациента также берется кровь на анализ, расшифровкой которого занимается квалифицированный специалист.
При иерсиниозе могут обнаружиться такие изменения в гематологических показателях: анемия, увеличенный показатель СОЭ, лейкоцитоз, увеличение количества эозинофилов, при этом число лимфоцитов уменьшается. Микробиологическая диагностика поможет поставить точный диагноз. Больше о диагностике иерсиниоза узнайте из этой статьи.
Патогенез
Входными воротами иерсиниозной инфекции является ЖК тракт. Микроорганизмы в большинстве случаев через полость рта проходят транзитом и значительно реже смогут повреждать слизистую желудка и внедряться в ткани, а затем проникать в регионарные лимфоузлы, вызывая клинику шейного лимфаденита/фарингита (катаральный синдром). Основная масса возбудителя иерсиниозов попадает в желудок и в тонкий кишечник, где проникает в слизисто-подслизистый слой, вызывая воспаление с развитием илеита или острого аппендицита. Некоторая часть микроорганизмов в толщу тканей не проникает, а фиксируется на поверхности слизистой кишечника, выделяя экзотоксин с развитием клинической симптоматики диарейного синдрома, а при попадании в толстую кишку иерсинии вызывают воспаление с развитием колитического синдрома.
Далее микроорганизмы проникают из стенки кишки в солитарные фолликулы и мезентериальные лимфоузлы. В случаях преодоления лимфатического барьера развивается фаза гематогенной диссеминации. В процессе разрушении микроорганизмов выделяется эндотоксин, который попадая в кровь поражает ЦНС и вегетативную нервную систему. Иерсинии с током крови разносятся по организму и попадают в паренхиматозные органы, что приводит к развитию в печени селезенке, легких вторичных патологических изменений в этих органах. У больных с иммунодефицитом заболевание может протекать в виде сепсиса.
Иерсинии обладают выраженным сенсибилизирующим действием, что проявляется в виде гиперартралгий. Характерен выраженный иммунный ответ. За бактериальным периодом часто развиваются реактивные состояния (синдром Рейтера, узловатая эритема, моно/олигоартриты и др.).
Yersinia pseudotuberculosis служит пусковым механизмом развития коллагенозов. Иммунитет обеспечивается гуморальными/клеточными факторами защиты, ведущим из которых является фагоцитоз. Специфические антитела обнаруживаются 6-8 день болезни, титр которых постепенно нарастает. Иммунитет нестойкий, формируется медленно, сохраняется на протяжении года. Схематически стадии патогенеза представлены на рисунке выше.
Эпидемиология
Бактерии обитают в почве и попадают в организм человека с помощью переносчиков – различных животных: свиней, кошек, собак, КРС, птиц, кроликов. Заражение от больного человека возможно, но наблюдается крайне редко и не имеет в эпидемиологическом отношении никакого значения. Источником инфекции в период вспышек в городах становятся грызуны, скопления которых и формируют эпидочаг. Больные крысы и мыши обитают в погребах и овощехранилищах. Их испражнения попадают на овощи и в резервуары с водой.
Механизм передачи — фекально-оральный, реализующийся алиментарным и водным путями.
- Заражение происходит при употреблении в пищу продуктов питания, прошедших неполноценную термическую обработку: плохо проваренного мяса, не кипяченого молока, а также сырой воды, загрязненной иерсиниями.
- Встречается контактно-бытовой путь передачи инфекции среди лиц с низкой гигиенической культурой.
- Описаны случаи иерсиниоза после переливания инфицированной крови.
Заражение животных происходит при употреблении корма или воды, загрязненных землей, инфицированной иерсиниями. Контактный путь передачи возбудителя обусловлен содержанием животных в антисанитарных условиях.
Люди отличаются низкой восприимчивостью к иерсиниозу. Лица, имеющие здоровую иммунную систему, практически не страдают клиническими формами инфекции. Дети, пожилые люди и лица с ослабленными защитными силами тяжело переносят заболевание. Бактерии, проникая в организм, прикрепляются к эпителию слизистой кишечника и разрушают его. Такие процессы приводят к формированию развернутой клинической картины заболевания. В группу риска входят лица, работающие в животноводстве, птицеводстве и на пищеблоках.
Классификация
В основу клинической классификации иерсиниоза положено несколько признаков, в соответствии с чем выделяют:
- Гастроинтестинальную форму с различными вариантами течения (гастроэнтерит, гастроэнтероколит, энтероколит).
- Абдоминальную форму (острый аппендицит, мезентериальной лимфаденит, терминальный илеит).
- Генерализованную форму (смешанный и септический вариант).
- Вторично-очаговую (узловатая эритема, артрит, синдром Рейтера).
По тяжести течения: легкую, среднетяжелую и тяжелую.
По течению: острое (до 1 месяца), затяжное (3-6 месяцев) и хроническое (после 6 месяцев).
Псевдотуберкулез (синоним «дальневосточная лихорадка») также может протекать с разными вариантами клинического течения с развитием изолированных/смешанных синдромов. Выделяют скарлатиноподобную, артралгическую, абдоминальную, смешанную форму и септический вариант течения.
Последствия
Особую опасность представляет развитие аутоиммунных процессов и воспалений внутренних органов. Сложность представляет лечение аппендицита при иерсиниозе. Опасно также развитие менингита и остеомиелита. В целом прогноз благоприятен. В большинстве случаев заболевание имеет доброкачественное течение.
Летальный исход при иерсиниозе – это довольно редкое явление. Наиболее неблагоприятным осложнением является заражение крови. Абдоминальная форма способна вызывать флегмонозный аппендицит и даже перитонит. Иерсиниоз может привести к осложнениям, представляющим угрозу для жизни.
В некоторых случаях инфекционный процесс становится причиной летального исхода. Многие осложнения этого заболевания требуют оперативного вмешательства. Для того чтобы предотвратить развитие неприятных последствий, необходимо вовремя обращаться к врачу при появлении первых симптомов.
Причины
Этиология
Yersinia enterocolitica/Yersinia pseudotuberculosis представляют собой грамотрицательные короткие (0,8-2 х 0,5-0,8 мкм) палочки (рис. ниже), имеющие капсулоподобную субстанцию, факультативные аэробы, не образуют спор, образуют эндотоксин. Имеют жгутиковый (Н-) и соматический (0) антиген. Вирулентность бактерий Yersinia ассоциируется с наличием плазмиды pYV и pVM 82, которые кодирует комплекс белков, предназначенных для нейтрализации иммунокомпетентных клеток человека/животного.
Хорошо сохраняются во внешней среде при температуре от +4 до 400 С, чувствительны к дезинфицирующим растворам, воздействию солнечного света, высушиванию, но могут длительно сохраняться в холодильнике при температуре до -20°С. Иерсинии погибают практически мгновенно при кипячении, способны длительно существовать и размножаться в пищевых продуктах. Иерсиниозы характеризуются сезонным подъем заболеваемости: пик заражения Y. enterocolitica приходится на февраль – май, а Y. pseudotuberculosis — на март/май.
Эпидемиология
Обе нозоформы инфекций (псевдотуберкулез и кишечный иерсиниоз) имеют фекально-оральный механизмом передачи. Факторами передачи чаще всего при иерсиниозе являются зараженные мясные продукты, овощи, молоко; при псевдотуберкулезе – овощные. Факторами передачи возбудителя являются в основном овощи/корнеплоды и корнеплоды (капуста, репчатый/ зеленый лук, морковь, свекла) и молочные продукты, которые не прошли термическую обработку. Водный фактор (употребление инфицированной воды из открытых водоемов) может явиться причиной заражения обоими видами инфекций.
Основной резервуар возбудителя иерсиниоза – мелкие дикие грызуны (полевки, суслики, песчанки землеройки, сурки, крысы), в том числе и синантропные (крысы, мыши), свиньи и другие дикие/домашние животные, которые обсеменяют почву, продукты и воду на фермах, овощехранилищах, предприятиях общественного питания, помойках, местах проживания людей. В популяции грызунов возбудитель передается алиментарным путем, через инфицированный корм и воду. Зараженные грызуны инфицируют продукты, воду, растительность путем выделения иерсиний с калом и мочой.
Этиология
Yersinia
Возбудителем иерсиниоза является микроорганизм Yersinia, который относится к семейству Энтеробактерий. Эта подвижная полиморфная бактериальная палочка отрицательно окрашивается по Граму и выживает в факультативно-анаэробных условиях — бескислородных. Иерсинии имеют перитрихиально расположенные жгутики, обеспечивающие подвижность, и не образуют спор.
Микроб отлично переносит низкие температуры: растет и размножается в пищевых продуктах при 4-6 °С. Благодаря такой особенности бактерий иерсиниоз в простонародье получил название «болезнь холодильников». Излюбленными местами обитания микробов являются кондитерские и хлебобулочные изделия, молоко и сливочное масло. Иерсинии активно размножаются в овощных салатах при идеальной для них температуре 25 – 29°C.
Иерсинии устойчивы к факторам внешней среды: выживают после замораживания и оттаивания, долгое время сохраняют свои патогенные свойства в воде и почве. Бактерицидным действием в отношении иерсиний обладают прямые солнечные лучи, кипячение, ультрафиолетовое облучение, окислители и химические дезинфектанты.
Благодаря факторам патогенности микробы вызывают развитие патологии. В процессе своей жизнедеятельности бактерии выделяют три вида токсинов – энтеротоксин, цитотоксин и эндотоксин. Энтеротоксин активизирует аденилатциклазу энтероцитов, повышает проницаемость их мембран для воды и электролитов, вызывает диарею и дегидратацию.
Факторы патогенности иерсиний:
- Отрицательная окраска по Граму указывает на наличие капсулы.
- Жгутики, обуславливающие активное передвижение микроба после внедрения в организм человека.
- Способность возбудителя к адгезии и колонизации слизистой кишечника.
- Адгезины, вызывающие артропатию.
- Протеаза, разрушающая IgA и облегчающая проникновение через слизистую оболочку внутренних органов.
- Белки наружной мембраны, обеспечивающие беспрепятственное проникновение микробов в глубоко лежащие ткани.
- Липополисахариды клеточной стенки обуславливают токсичность иерсиний.
Сложная антигенная структура бактерий объясняет своеобразие патогенеза заболевания, разнообразие клинических проявлений, широкий диапазон выраженности токсикоза и полиморфизм органных поражений.
Симптомы
Клинические симптомы иерсиниоза
Симптоматика иерсиниоза многообразна и определяется клинической формой заболевания. Наиболее часто иерсиниоз манифестирует в форме энтероколита, для которого характерно острое начало, проявляющееся болевым синдромом в эпигастрии/правой подвздошной области живота, реже — в виде разлитых болей, повышения температуры в пределах 37,5-39°C, тошноты, озноба. Расстройства стула и рвота как правило отсутствуют. Пациенты жалуются на боли в мышцах, суставах, пояснице. Отмечается интоксикации I и II степени. Иногда эти заболевания протекают по типу пищевой токсикоинфекции с расстройством стула. При присоединении явления колита отмечаются спазм сигмы тенезмы, в кале кровь и слизь. При тяжелом течении — повышение температуры до 39-40°C, выраженная интоксикация, длительная диарея, рвота, обезвоживание.
В некоторых случаях после явлений гастроэнтерита через несколько дней/одновременно с ним усиливаются боли в правой подвздошной области и появляются симптомы раздражения брюшины. В крови — увеличение СОЭ до 20-40 и более мм/час и лейкоцитоз (8-10 тыс.). Процессы в аппендиксе могут быть выражены в различной степени (катаральный, флегмонозный, гангренозный). В зависимости от степени изменений заболевание может протекать легко и без оперативного вмешательства, но может быть длительным и тяжелым с периодическими обострениями, приступами болей в животе и с подъемом температуры. Отмечается увеличение воспаленных регионарных мезентериальных лимфоузлов.
В ряде случаев иерсиниоз у взрослых не ограничивается проявлениями регионарно-очаговых реакций и после явлений энтероколита, гастроэнтерита, мезентериального лимфаденита инфекция попадает в кровь, вызывая вторично очаговые поражения органов или генерализованный процесс.
Заболевание манифестирует головной болью, ознобом, болями в мышцах/суставах, повышением температуры иногда 40°C и выраженными явлениями интоксикации. Общее состояние тяжелое, у части больных может появляться коре/краснухоподобная без четкой локализации, иногда по всему телу, характер которой может изменяться. Характерны припухание и гиперемия ладоней и стоп с последующим пластинчатым шелушением. В более тяжелых случаях развивается паренхиматозный гепатит с нарушениями функции печени и желтухой, увеличивается селезенка. Печень увеличена, болезненная. Могут отмечаться симптомы панкреатита. Заболевание длится до 3-4 месяцев и больше, сопровождается появлением новых поражений, которые по времени совпадают с рецидивами.
Довольно часто отмечается поражение суставов, лихорадка, боли в животе, диарея. В процесс вовлекаются большие и малые 2-4 сустава (коленные, межфаланговые, голеностопные). В области пораженных суставов наблюдается отечность, покраснение, повышение температуры, РОЭ, лейкоцитоз. Протекает с обострением и имеет сходства с артритом/полиартритом. Продолжительность от 7-15 дней до 5-12 месяцев. Одновременно с артритом может регистрироваться синдром Рейтера и поражение глаз.
В последнее время участилась септическая форма иерсиниоза, особенно среди лиц пожилого возраста, у страдающих диабетом, заболеваниями печени. У таких больных отмечается длительная температура септического характера, которая сопровождается потливостью, приступами болей в животе. Реже развиваются явления и симптомы менингита. При внутрибольничных вспышках иерсиниоз может протекать с фарингитом, выраженной гиперемией зева, увеличением миндалин, реже — подчелюстных лимфоузлов.
Формы
Иерсиниоз может принимать разные обличия. Чаще всего заболевание протекает с поражением кишечника. Все же специалисты не могут предположить, каким образом инфекционная болезнь будет развиваться. Выделяют четыре основные формы иерсиниоза:
- Гастроинтестинальная, характеризующаяся поражением желудочно-кишечного тракта (ЖКТ).
- Генерализованная, которая протекает по типу сепсиса.
- Абдоминальная, которая чаще всего развивается в виде острого аппендицита.
- Вторично-очаговая, поражающая внутренние органы.
Это лишь условная классификация. На практике может быть так, что заболевание начинается с поражения тонкого кишечника, потом переходит в генерализованную форму с дальнейшим развитием вторично-очаговых изменений. С учетом течения патологического процесса иерсиниоз бывает острым, затяжным и хроническим.

Гастроинтестинальная
Проявляется в виде симптомов поражения пищеварительного тракта. На фоне повышенной температуры и общей слабости появляется тошнота, рвота, а также боли в животе. В некоторых случаях болевая вспышка носит разлитой характер, но чаще всего неприятные ощущения локализуются в районе пупка и внизу живота. Далее присоединяется диарея.
У человека может быть до пятнадцати позывов к дефекации за день. Понос приводит к сильному обезвоживанию организма. Описаны такие клинические случаи, когда единственным клиническим проявлением иерсиниоза была диарея. Гастроинтестинальная форма также может вызывать и другие неприятные симптомы: насморк и кашель, склерит и конъюнктивит, боль и жжение при мочеиспускании.
Симптомы псевдотуберкулеза у взрослых
Псевдотуберкулез (дальневосточная лихорадка) протекает с определенной цикличностью, а клиническая картина отличаются полиморфизмом. Типичными проявлениями начала болезни являются признаки развития токсико-аллергического синдрома и изменения в желудочно-кишечном тракте. Для периода разгара характерна выраженная лихорадка и другие симптомы интоксикации, признаки органных поражений, появление экзантемы. Продолжительность периода разгара определяется тяжестью и варьирует в пределах 2-15 дней. Подавляющее большинство пациентов (около 80%) переносят острую форму заболевания, для которой характерно острое начало с выраженностью симптомов на первой неделе заболевания.
Наиболее часто больные жалуются на головную боль, слабость, мышечные и суставные боли. Ведущим признаком этого периода является лихорадка с субфебрильной температурой и ознобом. У ряда пациентов отмечается катаральный синдром, покашливание, насморк, гиперемия конъюнктивы, гиперемия слизистой ротоглотки. Почти у 50% больных в первые 3-4 дня появляется сыпь, симптом «капюшона»(гиперемия кожи шеи и лица), симптом «перчаток» и «носков» (гиперемия и отечность стоп и ладоней) – рис. ниже.
Почти у 84% случаев псевдотуберкулез у взрослых манифестирует экзантемой. Сыпь носит скарлатиноподобный/кореподобный мелкоточечный характер с локализацией в локтевых сгибах, на груди, животе. Элементы сыпи в большинстве случаев обильные, реже — скудная едва заметная сыпь в естественных складках. Геморрагический характер сыпи локтевых и коленных сгибов и шейной складки встречается 10-15% больных. При рецидивах заболевания могут выявляться на тыльной поверхности стоп/передней поверхности голени элементы узловатой эритемы. После угасания сыпи зачастую появляется мелкопластинчатое отрубевидное шелушения кожы пальцев рук и ног (рис. ниже).
Вовлечение в патологический процесс желудочно-кишечного тракта проявляется болями в правой половине живота и бывают чрезвычайно интенсивными. Для большинства случаев характерна симптоматика гастроэнтерита или гастроэнтероколита (реже).
Диарейный синдром обильный до 7-9 раз в сутки, стул жидкий с примесью слизи. Печень увеличена и может сопровождаться симптомами паренхиматозного гепатита: темной окраской мочи, желтушностью склер/кожи, гипербилирубинемией.
Клиническим проявлением вовлечения в процесс суставов являются артралгии, которые встречаются почти у четверти пациентов. Как правило, поражаются различные суставы чаще всего крупные суставы конечностей. При развившемся артрите развиваются местные воспалительные изменения кожного покрова над суставом, отечность и сглаженность конфигурации сустава.
Артралгии могут держаться в течение 2-3 недель или проходить самостоятельно за несколько дней. В большинстве случаев проявления мочевого синдрома умеренно выражены. У больных с тяжелыми формами болезни отмечаются изменения со стороны почек вплоть до развития олигурии, нарушения концентрационной функции почек, азотемии.
Псевдотуберкулез и иерсиниоз
Псевдотуберкулез, или экстраинтестинальный иерсиниоз, это заболевание, возбудителем которого является Yersinia pseudotuberculosis. Инкубационный период может длиться до трех недель. Это инфекционное заболевание способно поражать пищеварительный тракт, опорно-двигательный аппарат и кожные покровы.
Внимание! Псевдотуберкулез не имеет ничего общего с палочкой Коха, которая вызывает появление туберкулеза. Просто он вызывает схожие морфологические изменения в паренхиматозных органах.
Псевдотуберкулез и иерсиниоз вызывается микроорганизмами той же разновидности. Клиническая картина этих патологий очень схожа. В первом случае, все начинается с появления симптомов общей интоксикации, выраженных головных болей, покраснения и отечности горла, болей в суставах и мышцах. Язык приобретает грязно-серый цвет.
По истечении двух–четырех недель на теле начинают появляться красные точки. Сыпь обычно проходит через одну неделю, а на ее месте остается чешуйчатое шелушение. Главным симптомом недуга является появление сыпи на руках и ногах. Кожа в этих местах настолько сильно шелушится, что отходит целыми пластами.
Псевдотуберкулез получил свое название из-за того, что в лимфатических узлах и внутренних органах обнаруживались очаги, по виду напоминающие капсулы с творожистым содержимым. При этом эпителиодные клетки отсутствуют. Лечить псевдотуберкулез можно с помощью антибиотиков, гормональных средств, а также препаратов, устраняющих интоксикацию.
Питание при кишечной инфекции у взрослых
Заразиться псевдотуберкулезом можно фекально-оральным путем через такие продукты питания:
- немытые овощи и фрукты;
- недостаточная термическая обработка молочных, мясных и рыбных продуктов;
- кондитерские и хлебобулочные изделия, которые хранились в грязной таре;
- сухофрукты;
- вода, соки.
Дифференциальную диагностику, то есть сравнительный анализ, сможет провести специалист на основании результатов исследований. Проводится бактериологический анализ кала, крови. ДНК возбудителя можно обнаружить с помощью ПЦР-диагностики. Выявить антитела к возбудителю поможет иммунологический и серологический анализ.

Анализы и диагностика
В основе диагностики иерсиниозов, кроме клинической симптоматики следующие лабораторные тесты:
- ПЦР (Полимеразная цепная реакция) – определение ДНК микроорганизма в биоматериале (кале). Преимуществами ПЦР являются высокая чувствительность и специфичность, а также, быстрота получения результата.
- Серологические тесты (ИФА, РПГА). Определение специфических антител к энтеропатогенным иерсиниям в парных пробах сыворотки пациентов с интервалом 14 дней.
- Бактериологический метод — бак. посев крови, кала, мокроты, ликвора, мочи, мазка из зева (при всех формах).
Иерсиниозные инфекции необходимо дифференцировать с острыми кишечными инфекциями, аппендицитом, гепатитом другого генеза, тифопаратифозной инфекцией, артритами, инфекционным мононуклеозом, экзантемными инфекциями, острым респираторным заболеванием, ревматизмом, лептоспирозом, сепсисом, системными заболеваниями соединительной ткани.
Диагностические мероприятия
Диагностика иерсиниоза начинается с выслушивания жалоб, сбора анамнеза и внешнего осмотра больного. Специалисты собирают сведения о симптомах и времени их появления, течении заболевания и обстоятельствах, при которых произошло заражение — контактах с больными животными, употреблении сырой воды и плохо проваренных продуктов питания.
- Лабораторная диагностика заключается в проведении анализа крови и составлении иммунограммы. В гемограмме — анемия, лейкоцитоз, лимфопения, эозинофилия, увеличение СОЭ; в иммунограмме — антигены и антитела к возбудителю иерсиниоза.
- Основным методом диагностики иерсиниоза является бактериологический. Возбудителя выделяют из испражнений, крови, желчи и ликвора больных людей. В лаборатории исследуют мокроту или смыв со слизистой оболочки зева. Взятый у пациента биоматериал засевают на специальные питательные среды, на которых возбудитель инфекции свободно растет и размножается. Сначала делают посев в жидкие среды накопления и ставят пробирки в холодильник. На 3 или 5 сутки пересевают культуру на пластинчатые селективные среды Эндо и Плоскирева, помещают чашки в термостат. После инкубации в специальных условиях оценивают колонии бактерий. Затем выделяют чистую культуру и идентифицируют микроб до рода и вида путем высева в пестрый ряд Гиса для изучения биохимических свойств. Окончательное типирование проводят с помощью диагностических агглютинирующих сывороток. Иерсинии также выделяют из объектов окружающей среды и пищевых продуктов. Бактериологическая диагностика дает хорошие и точные результаты, но занимает много времени.
- Серодиагностика позволяет получить результаты в более короткие сроки. В крови определяют антигены возбудителя с помощью ИФА, РИФ, РАЛ и РНИФ. Серологическая диагностика иерсиниоза включает постановку развернутой реакции агглютинации по Видалю с соответствующими диагностикумами и реакцию пассивной гемагглютинации с антигенным эритроцитарным диагностикумом.
- Генетический анализ — выявление ДНК возбудителя в исследуемом материале путем постановки ПЦР.
- Всем пациентам требуется консультация специалистов в области гастроэнтерологии, кардиологии, нефрологии, неврологии.
- Для выявления имеющихся осложнений проводят ЭКГ, ЭхоКГ, УЗИ внутренних органов, КТ, МРТ, рентгенографию.
Иерсиниозы у детей
Иерсиниоз у детей протекает аналогично взрослым, однако имеется ряд особенностей. Типичные симптомы иерсиниоза у детей включают выраженную диарею и абдоминальный синдром. Стул жидко-кашицеобразный до 10 раз в сутки, реже с прожилками крови. Характерно острое начало, температура, нарушение аппетита, у маленького ребенка – беспокойство/заторможенность, появление рвоты, обложенность языка, бледность кожных покровов.
У детей раннего возраста возможно развитие тяжелых форм гастроэнтероколита с эксикозом и токсикозом, развивающихся на фоне многократной диареи и рвоты (до 20 раз в сутки). У детей старшего возраста длительно сохраняется выраженный абдоминальный синдром с болями в животе в правой подвздошной области, метеоризмом и синдром общей интоксикации при относительно умеренных проявлениях энтерита.
У 5-12% детей появляется экзантема в виде пятнисто-папулезной сыпи (симптом «перчаток» и «носков»), в области суставов на фоне склерита и «летучих» артралгий. Характерны изменения на языке («малиновый» язык), незначительное увеличение печени, шелушение кожи после экзантемы, панкреатопатии.
Реконвалесценция у детей старшего возраста наступает после 3–7 дней болезни, а у грудных детей — на 2-й неделе.
Для подростков и детей школьного возраста характерна абдоминальная форма иерсиниоза, частое развитие желтушного/безжелтушного паренхиматозного гепатита и артритов, развивающихся на фоне лихорадки и интоксикационного синдрома.
У детей до года, имеющим отягощенный преморбидный фон (синдром мальабсорбции, иммунокомпрометация, дистрофия, болезни крови, микст-инфекции, диабет) может происходить генерализация заболевания, протекающая со стойкой длительной гипертермией с периодами ознобов/потливости, срыгивания на фоне умеренной диареи, потери массы тела, синдрома диссеминированного внутрисосудистого свертывания, гепатолиенального синдромома, повторными высыпаниями, лимфаденопатией. Вне очагов кишечного иерсиниоза наиболее трудны для диагностики клинические варианты иерсиниоза, протекающего в виде фарингита, высыпаниями, сходными с различными токсико-аллергическими/инфекционными экзантемами.
Наиболее патогномоничные симптомы псевдотуберкулеза у детей — диспептические проявления и боли в животе, а также экзантема, развивающаяся на фоне лихорадки и синдрома интоксикации. Клинические проявления псевдотуберкулеза у детей в начальном периоде манифестируют лихорадкой до 39–40°С, выраженной интоксикацией, рвотой, головокружением, снижением аппетита, головной болью.
Жалобы на першение в горле, миалгию, артралгию, при осмотре — «малиновый язык» с разлитой гиперемией зева, лимфаденопатия, гиперемия и одутловатость лица с пастозностью век, бледностью кожи в носогубного треугольнике. Отмечаются симптом «капюшона», выраженные боли в животе, запор, а у детей младшего возраста – диарея. Патогномоничен выраженный симптом «перчаток»/«носков», сыпь сохраняется на протяжении 3–7 дней с дальнейшей пигментацией и шелушением кожи в области ногтевых фаланг, ладоней и стоп, мочек ушей, брюшной стенки, поясницы.
Для детей старше 5 лет универсальным проявлением заболевания является абдоминальная («псевдоаппендикулярная») форма, обусловленная развитием катарального аппендицита, мезаденита, терминального илеита.
Часто встречаются осложнения в виде абсцессов, деструктивного аппендицита, разлитого перитонита и реактивного панкреатита. При неблагоприятном течении возможно присоединение суставного синдрома. У детей старшего возраста, особенно у девочек в пубертатном периоде частыми и тяжелыми проявлениями являются артриты средних/крупных суставов конечностей с дальнейшим анкилозированием и деформацией, выраженные миокардиальные нарушения. Относительно редко у детей заболевание протекает в форме фарингита и энтерита. Псевдотуберкулезный сепсис у детей наблюдается крайне редко. Тяжелые формы часто дополняют пневмония и пиелонефрит, реже — менингит, полинейропатия.
Симптоматика
Инкубация иерсиниоза составляет 1-6 дней. Микробы попадают в ЖКТ, активно размножается в эпителиоцитах кишечника и повреждает их. Симптомы иерсиниоза у больного проявятся очень быстро, если доза бактерий и их вирулентность будут высокими, а состояние иммунной системы слабым. Бактерии захватываются тканевыми макрофагами. Часть их погибает, выделяя эндотоксин, а другая часть попадает в лимфоидную и кровеносную систему. Диссеминация микроорганизмов по всему организму является пусковым механизмом для возникновения периода клинических проявлений.
Клиника заболевания представлена несколькими синдромами.
- Токсический синдром проявляется лихорадкой до 38-40 °С, сохраняющейся 7-10 дней, ознобом, цефалгией, вялостью, миалгией, артралгией, потерей аппетита, расстройством ЦНС.
- Диспепсический синдром – тошнота, рвота, понос. Причиной боли в животе является нарушение чувствительности нервных окончаний, расположенных в стенке кишечника. Причиной подобного повреждения является воспаление, вызванное патогенными микроорганизмами. Болезненные ощущения возникают в эпигастрии, около пупка, в правом углу живота.
-
кожные высыпания
Экзантематозный синдром — основными элементами высыпаний на коже являются крупные папулы, кольцевидные пятна, геморрагии в виде мелких точек, локализованные на ногах и руках по типу «носков» и «перчаток», сопровождающиеся жжением и шелушением.
- Артропатический синдром – боль в суставах, отечность, ограничение подвижности.
- Катаральный синдром — першение и боль в горле, насморк, кашель, конъюнктивит, слезотечение, гиперсаливация.
- Лимфаденопатический синдром – увеличение лимфоузлов, с их неподвижностью и безболезненностью.
- Дизурический синдром — боль, жжение и рези при мочеиспускании, учащение или урежение мочеиспускания.
- Вегетативные признаки – потливость, колебания давления, мраморность кожи.
Иерсиниоз начинается остро и протекает по типу гастроэнтерита. После возникновения всех симптомов заболевания кишечная инфекция может приобретать генерализованную форму с поражением внутренних органов, не относящихся к пищеварительной системе. Во время разгара болезни с учетом особенностей клинической картины устанавливают форму инфекции – гастроинтестинальную, абдоминальную, генерализованную, вторично-очаговую, а также степень тяжести патологического процесса.
После проведения этиотропного лечения наступает выздоровление, во время которого полностью погибают патогенные микробы, восстанавливаются пораженные клетки внутренних органов и их функции. Летальность при иерсиниозе относительно низкая.
Морфофункциональные формы патологии:
- Гастроинтестинальная форма встречается чаще всего и проявляется признаками интоксикации, диспепсии, сыпью на коже, катаром, артропатией, гепатоспленомегалией, лимфоаденопатией. Больные жалуются на постоянную или схваткообразную боль в эпигастрии и около пупка, тошноту, рвоту, зловонный понос, озноб, миалгию, слабость. Частота стула варьируется от 4 и до 20 раз в сутки. В кале содержится слизь, кровь и гной. Затем появляется артралгия, насморк и кашель, конъюнктивит, дизурические расстройства. Заболевание длится от 2 до 14 дней и заканчивается полным выздоровлением. Волнообразный характер инфекции приводит к дегидратации организма.
- Абдоминальная форма протекает по типу брыжеечного лимфаденита, острого аппендицита или терминального илеита. Болевой синдром сопровождается признаками интоксикации и диспепсии. У больных увеличивается печень, селезенка и лимфоузлы, появляется миалгия, артралгия и экзантема.
- При генерализованной форме клиническая симптоматика весьма разнообразна. У больных температура тела поднимается выше 40 градусов, имеются признаки артралгического и катарального синдромов. На третий день болезни на ладонях и подошвах появляется сыпь. Среди диспепсических явлений преобладает боль в животе, тошнота, рвота, диарея. Затем понижается кровяное давление, нарушается сознание, возникает одышка, тахикардия, бледность кожи, появляется геморрагическая сыпь. Септическая форма отличается высокой летальностью.
- Смешанная форма проявляется симптомами генерализованной иерсиниозной инфекции с прогрессированием гепатоспленомегалии и поражением внутренних органов. У больных развивается воспаление печени, легких, почек, мозговых оболочек иерсиниозной этиологии с характерными клиническими проявлениями. Увеличиваются шейные лимфоузлов, возникает миалгия, сердцебиение, кардиалгия, дизурия.
- Вторично-очаговая форма является следствием одной из вышеперечисленных форм. Она развивается спустя месяц после острой кишечной инфекции. В организме больных формируется патологическая реактивность, и развивается аутоиммунное воспаление внутренних органов. Возникает асимметричный полиартрит или моноартрит с отечностью суставов, болью и гиперемией кожи; узловатая эритема с подкожными узелками на бедрах; энтероколит с болью в животе и нарушением стула. Миокардит длится недолго и отличается благоприятным течением. Возможно развитие болезни Крона, остеита, конъюнктивита, тиреоидита, энтероколита.
Осложнения иерсиниоза довольно многообразны. К ним относится:
- Терапевтическая патология – воспаление печени, желчного пузыря, миокарда, поджелудочной железы;
- Хирургическая патология — воспаление червеобразного отростка, спаечный процесс в брюшной полости, прободная язва кишечника, воспаление брюшины, сепсис;
- Заболевания ЦНС — менингит, энцефалит, арахноидит;
- Заболевания мочевыделительной системы — гломерулонефрит;
- Патология костно-суставной системы — артриты, остеомиелит.
Заболевание имеет преимущественно благоприятный прогноз и доброкачественное течение. Пациенты полностью выздоравливают. Летальность заболевания низкая.
Профилактика
Специфическая профилактика до настоящего времени не разработана. Неспецифическая профилактика иерсиниоза/псевдотуберкулеза заключается в соблюдении личных и общественных санитарно-гигиенических норм, правил хранения и приготовления пищи. Большое значение в системе неспецифических профилактических мероприятий при иерсиниозной инфекции отводится борьбе с источником и резервуаром иерсиний — грызунами (дератизационным мероприятиям). Меры направленные на пути распространения иерсиниоза и псевдотуберкулеза включают строгий санитарный надзор за продуктами питания и системой водоснабжения, постоянный контроль за технологическим режимом хранения и обработки пищевых продуктов, не подвергающихся достаточной термической обработке.
Лечение
Лечение иерсиниоза проводят в условиях инфекционного стационара. Медикаментозное лечение заключается в назначении различных групп препаратов.
- Этиотропная терапия направлена на уничтожение иерсиний в организме человека. Больным назначают антибактериальные средства широкого спектра действия из группы фторхинолонов, макролидов, цифалоспоринов, защищенных пенициллинов. Антибиотики назначают после получения результатов определения чувствительности выделенных бактерий из биоматериала. Наиболее эффективными являются «Ципрофлоксацин», «Хлорамфеникол», «Цефтриаксон», «Амоксиклав», «Азитромицин».
- Дезинтоксикационное лечение способствует выведению токсинов из организма и устранению симптомов интоксикации — внутривенное введение коллоидных и кристаллоидных растворов: «Гемодеза», «Реополиглюкина», «Регидрона».
- Симптоматическая терапия направлена на уменьшение боли, воспаления, отека, жара – антигистаминные препараты: «Супрастин», «Тавегил»; НПВС: «Ибупрофен», «Диклофенак»; глюкокортикостероиды: «Преднизолон», «Гидрокортизон».
- Общеукрепляющее лечение позволяет пациентам быстрее выздороветь и восстановиться после тяжелого заболевания — витаминотерапия; ферментные препараты: «Панкреатин», «Креон»; пре- и пробиотики: «Линекс», «Аципол».
- Иммуномодуляторы повышают общую сопротивляемость организма к патогенным болезнетворным агентам – «Имунофан», «Метилурацил».
При отсутствии своевременного лечения иерсиниозная инфекция приобретает хроническое течение. У больных увеличивается риск развития тяжелых осложнений, удлиняется срок выздоровления и появляются нежелательные последствия.
Список источников
- Ющук Н. Д., Ценева Г. Я., Кареткина Г. Н., Бродов., Л. Е. Иерсиниозы. — М.: Медицина, 2003. — 208 с.
- Сомова Л.М., Андрюков Б.Г., Плехова Н.Г., Плехова Н.Г. ПРОБЛЕМА ИЕРСИНИОЗОВ В СОВРЕМЕННОМ МИРЕ // Международный журнал прикладных и фундаментальных исследований. – 2019. – № 12-4. – С. 661-667.
- Ценева Г.Я., Воскресенская Е.А., Солодовникова Н.Ю. и др. Биологические свойства иерсиний и лабораторная диагностика псевдотуберкулеза и иерсиниоза: Пособие для врачей. — СПб, 2001. — 60 с.
- Карбышева Н. В., Бобровский Е. А. Активность природных очагов и заболеваемость при иерсиниозной инфекции // Журнал инфектологии. 2016. Т. 8 (2). С. 52.
- Шестакова И. В., Ющук Н. Д., Балмасова И. П. Клинико-прогностические критерии различных форм и вариантов течения иерсиниозной инфекции // Тер. архив. 2009, т. 81,11: 24–32.
Клинические рекомендации
Профилактические меры важны для сохранения жизни человека. Здоровый образ жизни поможет предотвратить появление многих патологий, среди которых и иерсиниоз. Родители должны объяснить ребенку важность соблюдения правил личной гигиены. В противном случае могут создаться идеальные условия для активизации патогенной микрофлоры в кишечнике. Важно следить не только за хранением пищи, но и за качеством приготовления, особенно это касается продуктов животного происхождения.
Внимание! Работники пищеблоков используют прошлогодние овощи только после термической обработки, согласно требованию санпина.
Для приготовления салатов необходимо использовать исключительно доброкачественные овощи этого года. Профилактические мероприятия должны соблюдаться не только в повседневной жизни, но и в детских, лечебных и пищевых учреждениях. Обязателен контроль состояния водных источников. Также должна проводиться борьба с грызунами.
Овощи необходимо хранить в специально оборудованных помещениях. Это позволит избежать попадания испражнений грызунов, которые являются основными переносчиками возбудителей иерсиниоза. Более того, такие помещения должны подвергаться дезинфекции и хорошо проветриваться.
В целях безопасности овощи должны храниться в специально оборудованных с этой целью помещениях
Возможные осложнения
Иерсиниоз (клинические рекомендации важно соблюдать, чтобы предупредить негативные последствия болезни) без точного диагноза и должного лечения провоцирует серьезные нарушения в организме человека:
- Инфекционно-токсический шок.
- ДВС-синдром.
- Перфорацию кишечника.
- Перитонит.
- Спаечную болезнь.
- Сепсис.
- Мезаденит (поражение иерсинием регионарных лимфатических узлов).
- Вторичные очаги воспаления провоцируют артрит, менингит, миокардит, пиелонефрит.
- На фоне стимуляции иммунопатологических процессов развивается болезнь Крона, Рейтера, гепатит, перикардит.
- Абдоминальная форма иерсиниоза характеризуется терминальным илеитом, при затяжном протекании которого наблюдается некроз слизистой оболочки, развивается перитонит, стеноз дистальной области подвздошной кишки.
Чаще осложнения иерсиниоза появляются, если пациента поздно госпитализировали или болезнь протекает тяжело. Существующие хронические патологии, иммунодефицитное состояние, неправильно подобранное лечение также провоцируют серьезные последствия.
Существует серьезная смертная статистика (60%). Важно своевременно обратиться к врачу (семейному специалисту, инфекционисту или иммунологу), чтобы предупредить иммунодефицит и обострение патологических процессов. Иерсиниоз успешно лечится, если пациент соблюдает клинические рекомендации и находится под контролем врача.
Оформление статьи: Мила Фридан
Диагностика иерсиниоза
Поставить точный диагноз и подобрать максимально эффективное лечение врач сможет после комплексного медицинского обследования, позволяющее определить возбудителя.
| Название обследования | Описание | Цена |
| Общий анализ крови. | В крови увеличивается количество лейкоцитов, указывая на развитие воспалительного процесса, и меняется скорость оседания эритроцитов. Метод малоэффективный, по результатам врач может предположить бактериальное происхождение болезни. | от 1500 р. |
| Выделение возбудителя болезни. | Для исследований у пациента в первые 3 дня берут кровь и слизь из носоглотки. Через время врач назначает анализ кала и мочи. При необходимости у больного берут спинномозговую жидкость. | от 900 р. |
| Иммунологическое исследование крови. | Тесты проводят через 2 недели после начала болезни, чтобы антитела успели выработаться. | от 500 р. |
| Электрокардиография (ЭКГ). | Обследование покажет изменения в работе сердечно-сосудистой системы. | от 150 р. |
| Эхокардиография (ЭхоКГ). | Ультразвуковые сигналы позволяют обследовать все структуры сердца и определить проблемы с ним. | от 320 р. |
| Ультразвуковое исследование внутренних органов (УЗИ). | Помогает выявить патологические процессы при иерсиниозе, область поражения внутренних органов. | от 1600 р. |
| Компьютерная томография (КТ). | Специальное устройство позволяет комплексно обследовать весь организм больного при помощи рентгеновских лучей. Наиболее эффективный метод диагностики, который дает возможность отличить иерсиниоз от других заболеваний. | от 1300 р. |
При поражении внутренних органов патологическими процессами у пациента возникают характерные симптомы. Для подтверждения иерсиниоза врачи назначают пациентам дополнительные исследования, чтобы определить тяжесть заболевания.
Комплексная диагностика поможет врачу получить максимум информации для постановки диагноза, определить степень заболевания и форму патологии. На основании результатов пациенту подбираются лекарства для борьбы с иерсиниозом.
Диета
Диета при иерсиниозе играет роль в основном при диспепсических симптомах заболевания. При этом можно употреблять пищу только небольшими порциями. Наиболее благоприятными продуктами при остром течении являются:
- жидкие протертые каши на воде, желательно рисовая или овсяная;
- сухари;
- сухофрукты;
- паровые тефтели из белого мяса.
В дальнейшем на фоне лечения можно постепенно расширять рацион и включать привычные диетические блюда. При тяжелом течение иерсиниоза, а также в случае неукротимой рвоты, питание пациента временно осуществляется путем внутривенного введения специальных растворов белков, сахаров и жиров.
Только своевременно назначенная комплексная терапия гарантирует быстрое выздоровление пациента и прекращение неприятных симптомов иерсиниоза.
Будьте бережны и внимательны к своему здоровью – выберите подходящего вам врача и запишитесь на приём по телефону: 8 (для жителей Москвы и Московской области).
Этиотропная терапия
Лечение неосложненных форм иерсиниоза является медикаментозным. Лечится данная инфекционная болезнь с помощью различных средств (
). Базовыми лекарствами при лечении этого недуга являются антибиотики, которые предназначены для уничтожения болезнетворных бактерий, размножающихся в кишечнике у пациента. Подбор антибиотиков должен всегда осуществляться в соответствии с результатами антибиотикограммы, которую выполняет микробиологическая лаборатория.
Антибиотикограмма – это специальный бактериологический анализ, устанавливающий насколько чувствительны патогенные бактерии к различным типам антибиотиков. В помощь антибиотикам при иерсиниозе назначают добавочные медикаменты, которые выполняют различные задачи.
Пробиотики и эубиотики необходимы для восстановления и восполнения нормальной микрофлоры кишечника, которая часто бывает подавлена в период кишечной инфекции. Кроме того прием антибиотиков также угнетает рост собственной микрофлоры у пациента.
Нестероидные противовоспалительные препараты снижают симптомы интоксикации (
). Дезинтоксикационные средства способствуют выведению бактериальных токсинов из организма. При лечении вторично-очаговой формы иерсиниоза нередко прописывают глюкокортикоиды и иммуностимуляторы. Первые обладают выраженным противовоспалительным и иммунодепрессивным (
) эффектом. Иммуностимуляторы нужны для повышения общей резистентности (
) организма, они стимулируют размножение клеток иммунной системы и улучшают их взаимодействие между собой. Лечение осложненных форм иерсиниоза помимо вышеперечисленных медикаментов может еще включить и хирургическое лечение.
Лекарственные препараты, используемые в лечении иерсиниоза
| Название группы препаратов | Название препарата | Методика применения данного препарата |
| Антибиотики | Пефлоксацин | Этот препарат назначают по 400 мг 2 раза сутки. |
| Офлоксацин | Препарат нужно употреблять таким образом, чтобы максимальная суточная доза не превышала 800 мг. Обычно употребляют по 200 – 400 мг 2 раза в сутки. | |
| Ципрофлоксацин | Чаще всего его назначают в дозе 500 мг и кратностью применения 2 раза в день. | |
| Хлорамфеникол | Хлорамфеникол, в основном, назначают при наличии у пациента иерсиниозного менингита (или менингоэнцефалита). Дозу препарата высчитывают исходя из массы пациента. Рекомендуется на каждый килограмм массы тела назначать 70 – 100 мг в сутки. | |
| Цефотаксим | Назначают по 2 грамма 3 раза в сутки в виде внутривенных или внутримышечных инъекций (уколов). | |
| Цефтриаксон | Прописывают по 2 грамма 1 раз в день в виде внутривенных или внутримышечных инъекций (уколов). | |
| Ко-тримоксазол | Детям до 12 лет рекомендуется принимать по 1 таблетке 2 раза в сутки, старше 12 – по 1 – 3 таблетки 2 раза в сутки. | |
| Нестероидные противовоспалительные препараты | Ибупрофен | Пациенты старше 12 лет могут употреблять по одной таблетке (200 мг) 3 – 4раза в сутки. Максимальная суточная доза для них составляет 1200 мг (то есть в день нельзя принимать больше 6 таблеток). Детям с 6 и до 12 лет точно такие же таблетки разрешается принимать не более 3 – 4 раз в сутки (максимальная суточная доза 600 – 800 мг). |
| Диклофенак | Взрослым пациентам наиболее часто назначают по 100 – 150 мг препарата в сутки. Детям и подросткам дозу препарата высчитывают исходя из базового принципа 1 – 2 мг на 1 кг массы тела. | |
| Кетопрофен Органика | Выпускается в форме таблеток, покрытых пленочной оболочкой и капсул. При использовании первой формы выпуска следует употреблять данный препарат по одной таблетке два раза в сутки. При применении второй лекарственной формы рекомендуемый режим дозирования для взрослых и детей старше 14 лет должен составлять 4 капсулы в сутки. За один раз можно принимать не более двух капсул. Максимальная суточная доза препарата равняется 200 мг. | |
| Глюкокортикоиды | Преднизолон | Дозировки данных препаратов (преднизолона, гидрокортизона) подбираются индивидуально в зависимости от возраста, массы тела, характера патологии, ее тяжести, наличия сопутствующих заболеваний и осложнений. |
| Гидрокортизон | ||
| Иммуностимуляторы | Метилурацил | Взрослым назначают по 500 мг 1 – 6 раз в сутки. Максимальная суточная доза не должна превышать 3 граммов. Детям чаще всего прописывают по 250 мг препарата, который принимают не более 3 раз в сутки. |
| Натрия нуклеинат | Суточная доза не должна быть выше 1 – 2 граммов. Данный препарат врачи советуют принимать по 3 – 4 раза в день. Каждая таблетка содержит 250 мг препарата. | |
| Пентоксил | Пентоксил назначают по 200 – 400 мг 3 – 4 раза в сутки. | |
| Имунофан | Прописывают по 100 мкг один раз в день. Данный препарат используют в виде спрея. Одно нажатие на спрей, сопровождается выбросом 50 мкг препарата. Его распыляют в носовой полости. Таким образом, для того чтобы суточная доза составляла 100 мкг, пациенту необходимо в каждом из носовых ходов сделать одно нажатие на пульверизатор. | |
| Пробиотики и эубиотики | Линекс | По 1 – 2 капсулы 3 раза в сутки. |
| Аципол | Пациентам от 3 месяцев до 3 лет по одной капсуле 2 – 3 раза в день. Больным старше трех лет рекомендуется употреблять по 1 капсуле 3 – 4 раза в сутки. | |
| Бифидумбактерин | Детям старше 7 лет и взрослым назначают по 2 пакетика данного препарата. Кратность приема – 2 – 4 раза в сутки. Детям младше семи лет прописывают по одному пакетику 3 – 4 раза в сутки. | |
| Дезинтоксикационные средства | Гемодез-Н | Реализуется в форме раствора для инфузий. Раствор препарата вводят внутривенно (капельно). В сутки гемодез-н можно использовать 1 – 2 раза. Максимальная разовая доза для взрослых составляет 400 мл. Для детей объем лекарственного средства высчитывают в зависимости от их массы тела (2,5 мл на кг массы тела). Максимальная разовая доза зависит от возраста ребенка. |
| Неогемодез | Выпускается в той же форме что и гемодез-н (в виде раствора для инфузий). Для взрослых однократная доза не должна превышать 500 мл, а для детей от 5 до 10 мл на кг массы тела. В большинстве случаев, препарат вводят 1 – 2 раза в сутки. | |
| Ферменты | Панкреатин | Взрослым панкреатин следует принимать по одному драже 3 раза в сутки. Для детей дозировка подбирается индивидуально. |
| Панкреофлат | Взрослым назначают по 1 – 2 таблетки. Их принимают после каждого приема пищи. Для детей дозировка подбирается индивидуально. | |
| Абомин | Абомин обычно назначают по одной таблетке три раза в день. |
ПОДРОБНОСТИ: Свист в ушах и голове: причины и лечение
), фруктов (
Наиболее тяжелые проявления отмечаются у малышей при генерализованной форме иерсиниоза.
Кишечный иерсиниоз сопровождается болью и спазмами в животе, тошнотой, рвотой и жидким стулом. Патоген вызывает нарушения пищеварения, воспаление слизистой оболочки тонкого и толстого кишечника. В целом, симптоматика такая же, как в случае большинства желудочно-кишечных инфекций.
Реже проявляются аллергические реакции на возбудитель и выделяемые им токсины — высыпания в виде мелких или крупных пятен и прыщей. Иногда возникает боль и ограниченность движений в суставах рук и ног. Может наблюдаться увеличение печени и селезенки.
Родители и врачи в первую очередь обращают внимание на комплекс симптомов иерсиниоза у детей:
- проявления интоксикации организма (высокая температура, озноб);
- диспепсические расстройства (рвота, диарея);
- боль и покраснение горла, насморк, кашель;
- могут увеличиваться лимфатические узлы;
- высыпания на теле.
Иерсиниоз: расширяя традиционные представления о диагностике, лечении и диспансеризации больных
Иерсиниоз широко распространен на территории РФ, а стабильно низкий уровень официально регистрируемой заболеваемости не отражает истинного состояния проблемы. Иерсиниоз в настоящее время вышел за рамки чисто инфекционной патологии, став терапевтической проблемой из-за «слабой» лабораторной базы, используемой в практическом здравоохранении, проблем в выборе тактики лечения и реабилитации больных. Особую тревогу клиницистов вызывают неблагоприятные последствия перенесенного иерсиниоза, в частности, хронизация инфекционного процесса и формирование системных аутоиммунных заболеваний в исходе болезни [1].
Хотя в последние годы достаточно детально были описаны клинические проявления болезни, в том числе хроническое течение, и внесены значительные коррективы в понимание звеньев иммунопатогенеза, практикующие врачи знают, насколько трудно поставить диагноз, а главное, подобрать адекватное стадии болезни лечение больным.
Как показывает наш опыт, больные с иерсиниозом из-за полиморфизма клинических проявлений разных периодов болезни часто направляются не к инфекционисту, а к врачам других специальностей (гастроэнтерологам, ревматологам, эндокринологам, гематологам и др.), каждый из которых ставит диагноз, по сути, являющийся синдромальным, и, как следствие, назначает лишь симптоматическое лечение. Это утверждение основывается на данных многолетнего мониторинга за переболевшими иерсиниозом, согласно которым рецидивирующее течение среди госпитализированных регистрируется крайне редко (1,3%) и не соответствует реальным данным об истинной частоте развития рецидивов (от 15,8% до 44% в разные годы).
По-видимому, столь редкая госпитализация этих больных связана с отсутствием длительного амбулаторного наблюдения пациентов, перенесших иерсиниоз, в результате чего после выписки из стационара они выпадают из поля зрения инфекциониста, а развивающиеся рецидивы ошибочно трактуются другими специалистами. Однако же именно ранней диагностике и своевременно начатому лечению отводится ведущая роль в профилактике постиерсиниозных иммунопатологических заболеваний, приводящих к длительному снижению работоспособности и инвалидности больных.
Широко применяемые в практической медицине диагностические препараты и тест-системы обладают достаточно низкой чувствительностью и эффективностью [2, 3]. Многолетний мониторинг диагноза «иерсиниоз» у пациентов, госпитализированных в ИКБ № 2 г. Москвы, показал, что на протяжении последних десяти лет неуклонно растет число ошибочных диагнозов «иерсиниоз», что приводит к необоснованной антибиотикотерапии и длительной нетрудоспособности пациентов. Так, на догоспитальном этапе у 57,6% (колеблется от 50,9% до 66,3% в разные годы) пациентов ошибочно диагностируется иерсиниоз, и больные не получают адекватного лечения в специализированных отделениях клинических больниц общего профиля.
В инфекционном стационаре у 42% этих больных в качестве заключительного диагноза фигурировали другие инфекционные болезни (острые кишечные инфекции, ОРВИ, энтеровирусные заболевания, инфекционный мононуклеоз, геморрагическая лихорадка с почечным синдромом, вирусные гепатиты, генерализованный хламидиоз, лептоспироз, ВИЧ, бруцеллез, туляремия и др.) и у 58% — неинфекционная патология. Особую тревогу вызывает ошибочно диагностируемый на догоспитальном этапе иерсиниоз у 5,7–15,2% пациентов с острой хирургической патологией, требующей экстренного хирургического вмешательства [4, 5].
Нельзя не согласиться с мнением В. А. Орлова и соавт. (1991), что «большая часть диагностических ошибок обусловлена неправильным подходом к диагностическому процессу». По-видимому, только этим можно объяснить тот факт, что на протяжении десяти лет у 2,9–9,1% больных с подозрением на иерсиниоз в итоге диагностируются заболевания сердца и сосудов, у 2,8–6,4% — опухоли кишечника, легких и органов малого таза, у 2,9–7,1% — ходжкинская лимфома, лимфо- и миелолейкоз, у 2,8–6,1% — заболевания эндокринной системы (токсический зоб, тиреотоксикоз, аутоиммунный тиреоидит), у 2,1–12,1% — воспалительные заболевания половых органов.
По нашему мнению одной из главных причин диагностических ошибок, приводящих как к гипо-, так и к гипердиагностике иерсиниоза, является низкая информативность недостаточно специфичных методик и диагностических средств, а также несоблюдение имеющихся рекомендаций по диагностике иерсиниоза. В РФ имеются современные диагностические препараты, методы и питательные среды для индикации и идентификации Yersinia enterocolitica и антител к ним, но система их применения не унифицирована, а оценка специфичности несовершенна.
Лабораторная диагностика иерсиниоза должна включать бактериологические, иммунодиагностические и серологические методы. Основным методом является бактериологический — посев биологического материала больного (фекалий, мочи, смыва с задней стенки глотки, сгустка крови, мокроты, желчи, ликвора, операционного материала и др.), материала из внешней среды и от животных на питательные среды для выявления роста Y. enterocolitica с последующей идентификацией культуры. Исследованию должно подвергаться не менее четырех материалов (например, фекалии, моча, кровь, смыв с задней стенки глотки). Оптимальные сроки забора материала — первые 7–10 дней болезни. Крайне редко удается получить культуру Y. enterocolitica из материала больных с затяжным течением и вторично-очаговыми формами иерсиниоза.
Основными недостатками бактериологического метода являются низкая частота получения роста культуры — в среднем по РФ Y. enterocolitica выделяют в 2–3% проб 0,81%, и ретроспективность (окончательный результат на 21–28 день постановки) [2]. На протяжении более десяти лет в бактериологической лаборатории ИКБ № 2 г. Москвы удалось выделить Y. enterocolitica лишь в 0,2% взятых проб (только при генерализованной форме иерсиниоза), что согласуется с данными центра ГСЭН г. Москвы и в четыре раза хуже, чем в целом по РФ [2, 3].
Иммунодиагностические методы позволяют обнаружить антигены Y. enterocolitica в клиническом материале до 10-го дня от начала болезни (иммуноферментный анализ (ИФА), реакция коагглютинации (РКА), реакция иммунофлуоресценции (РИФ), реакция непрямой иммунофлуоресценции (РНИФ), реакция агглютинации и лизиса (РАЛ)). По данным производителей чувствительность тест-систем достигает 104–105 м. кл./мл, а эффективность исследования копрофильтрата и сыворотки в первые пять дней болезни составляет 83–85%. Перспективные методы — методы индикации и идентификации патогенных Y. enterocolitica по комплексу фенотипических признаков, связанных с ее детерминантами патогенности (тест-системы типа API (чувствительность 79%) и генетические методы диагностики и типирования иерсиний (полимеразная цепная реакция (ПЦР), мультипраймеровая ПЦР). К достоинствам ПЦР следует отнести быстроту выполнения анализа (до 6 ч), информативность, высокую чувствительность и специфичность. Однако в практической медицине самой уязвимой оказалась специфичность этой реакции. Метод иммуноблоттинга, позволяющий выявлять и идентифицировать белки (антигены) иерсиний с помощью антисывороток, в РФ используется неоправданно редко.
Для определения специфических антител к антигенам Y. enterocolitica используют серологические методы. Исследование необходимо проводить со 2-й недели болезни в парных сыворотках с интервалом 10–14 дней. Желательна 2–4-кратная динамика титра антител в парных сыворотках, что, однако, не всегда наблюдается на практике. В начале болезни наиболее информативна реакция ИФА с определением IgA, IgM и IgG, ELISA, на 3–4 неделях — ИФА, ELISA, реакция агглютинации (РА), РСК, А-БНМ. Для качественного определения антител класса IgA и IgG к факторам вирулентности патогенных штаммов Y. enterocolitica можно использовать метод иммуноблоттинга, используемый для дифференциальной и ретроспективной диагностики иерсиниоза. При хроническом течении иерсиниоза информативны ИФА с определением IgA и IgG и иммуноблоттинг.
Несмотря на большое число предлагаемых тест-систем и гарантирование различными фирмами высокой частоты обнаружения антигенов иерсиний или антител к ним (до 85%), в практическом здравоохранении чаще используются реакция непрямой гемагглютинации (РНГА) и РА, реально позволяющая диагностировать иерсиниоз лишь у каждого четвертого больного (25,3%): при абдоминальной форме — у 41,7% больных, при генерализованной форме — у 21,1% больных, при вторично-очаговой форме — у 30,8% больных. Крайне редко серологическими методами подтверждается гастроинтестинальная форма иерсиниоза (4,5%). Достоверной зависимости уровня антител к иерсиниям от тяжести течения иерсиниоза нет.
Достаточно часто (21,1% случаев) лечащие врачи трактуют однократное обнаружение в крови больных специфических антител к Y. enterocolitica как лабораторное подтверждение иерсиниоза. Однако у большинства пациентов (54,1%) титр не превышает 1:200, а значит, не может считаться лабораторным подтверждением клинического диагноза. Объяснение этого кроется в интенсивной циркуляции иерсиний в окружающей среде и среди населения. По материалам центров ГСЭН в РФ при обследовании здоровых лиц специфические антитела к Y. enterocolitica обнаруживаются в 0,4–4,4% проб [2]. Однако иммунная прослойка среди населения значительно выше — 18,2–19,6% [6, 7].
Титры антител к Y. enterocolitica в реакции прямой гемагглютинации (РПГА) и РА выше 1:200 регистрируются лишь у 45,9% больных. Однако однократность исследования крови упомянутыми методиками даже при высоком титре нельзя однозначно трактовать как иерсиниоз. Так, в нашей практике была пациентка с выраженным суставным синдромом, при динамическом исследовании крови которой антитела к Y. enterocolitica методом РА находились на постоянном уровне — 1:102 400, что свидетельствовало лишь о перенесенном иерсиниозе и не являлось показанием для назначения антибактериальной терапии.
Анализируя в целом рекомендации по лабораторной диагностике иерсиниоза и складывающуюся на практике ситуацию, можно констатировать, что лабораторная диагностика болезни остается на уровне начала 90-х годов. Причины кроются не только в использовании недостаточно эффективных методик, но и в несоблюдении имеющихся рекомендаций по диагностике иерсиниоза. Так, в большинстве случаев практические врачи в постановке диагноза опираются на однократное исследование материала, взятого от больного, и величину титра антител к Y. enterocolitica. Однако серологическим критерием диагноза «иерсиниоз» следует считать не столько достижение величины «диагностического» титра специфических антител, сколько его динамику при исследовании парных сывороток с интервалом 10–14 дней. Для повышения эффективности диагностики иерсиниоза мы рекомендуем исследовать сыворотки крови больных иерсиниозом минимум тремя методиками (например, РНГА, РСК и ИФА и др.).
Патогенез иерсиниоза. Выбор тактики ведения и медикаментозного лечения больных иерсиниозом напрямую зависит от патогенеза разных стадий болезни. Известно, что характер взаимодействия Y. enterocolitica с макроорганизмом зависит от набора факторов патогенности штамма, дозы инфекта, пути введения и иммунологической реактивности макроорганизма. С учетом имеющихся экспериментальных данных патогенез иерсиниоза у человека может быть представлен следующим образом. Y. enterocolitica проникают в организм человека перорально, и заболевание развивается после довольно короткого инкубационного периода — от 15 часов до 6 суток (в среднем 2–3 дня). Основная масса иерсиний преодолевает защитный барьер желудка. В желудке и двенадцатиперстной кишке развивается катарально-эрозивный, реже — катарально-язвенный гастродуоденит. Затем развитие патологического процесса может пойти в двух направлениях: либо возникнут местные воспалительные изменения в кишечнике, либо разовьется генерализованный процесс при лимфо- и гематогенной диссеминации Y. enterocolitica.
Если заболевание вызвано серотипами Y. enterocolitica, обладающими выраженной энтеротоксигенностью и низкой инвазивностью, то, как правило, развиваются локализованные в кишечнике процессы, проявлениями которых будут поражение желудочно-кишечного тракта (катарально-десквамативный, катарально-язвенный энтерит и энтероколит) и интоксикация.
Если Y. enterocolitica проникают в мезентеральные узлы, то развивается абдоминальная форма. Патоморфология иерсиниозного лимфаденита представляет собой сочетание инфекционно-воспалительных и иммунологических процессов. В аппендиксе воспалительный процесс чаще носит катаральный характер, но возможно развитие флегмонозного процесса с последующей деструкцией отростка и развитием перитонита. Гастроинтестинальная и абдоминальная формы иерсиниоза могут быть как самостоятельными, так и одной из фаз генерализованной формы.
Известны два пути генерализации иерсиниозного процесса — инвазивный и неинвазивный. Инвазивный путь проникновения Y. enterocolitica через эпителий кишки является классическим и наиболее изученным. Если заражение вызвано высоковирулентным штаммом Y. enterocolitica, то возможен неинвазивный путь проникновения через слизистую кишки внутри фагоцита.
В период реконвалесценции должно происходить освобождение организма от иерсиний и восстановление нарушенных функций органов и систем с исходом в клинико-лабораторное выздоровление. Однако такое благоприятное развитие событий возможно только при адекватном иммунном ответе и отсутствии иммуногенетических и эпигенетических маркеров неблагоприятного исхода. Диспансерное наблюдение реконвалесцентов в течение пяти лет после острого иерсиниоза показало, что исходами иерсиниоза могут быть:
1) клинико-лабораторное выздоровление (55,2%);
2) неблагоприятные исходы (29,2%):
а) с формированием хронического течения (57%);
б) с формированием патологических состояний и заболеваний, имеющих аутоиммунную природу (43%);
3) относительно неблагоприятные исходы с преобладанием инфекционно-воспалительного компонента (10,5%):
а) с обострением хронических воспалительных заболеваний (35,5%);
б) с формированием новых заболеваний с преобладанием инфекционно-воспалительного компонента (64,5%);
4) остаточные явления (непродолжительная субфебрильная лихорадка, периодические миалгии и артралгии, неврологические симптомы с вовлечением нервных сплетений и корешков, вегетативные реакции, астенический и ипохондрический синдромы, феномен интероцепции и др.) (5,1%).
Наилучший прогноз у больных в возрасте 19–25 лет. Среди них 71% выздоравливают. В то же время у 45% переболевших в возрасте 26–45 лет формируются различные по генезу патологические состояния, входящие в категорию неблагоприятных исходов иерсиниоза.
По нашим данным врачи диагностируют вторично-очаговые формы иерсиниоза чаще, чем они реально формируются. Это связано с отсутствием патогномоничных клинических проявлений вторично-очаговых форм иерсиниоза и их системностью. Группа больных с так называемой вторично-очаговой формой иерсиниоза не является однородной. К этой группе часто необоснованно относят как больных с патологическим процессом иерсиниозной этиологии (например, хроническим течением иерсиниоза), так и больных с хроническим течением постиерсиниозной инфекции, с формирующимися новыми острыми процессами неиерсиниозной этиологии и пациентов с аутоиммунной патологией. Такое положение дел требует от практикующего врача особого внимания и анализа клинико-лабораторных показателей, т. к. от их понимания зависит дальнейшая тактика лечения, а значит, исход всего патологического процесса.
У пациентов с хроническим течением иерсиниоза Y. enterocolitica продолжает длительно циркулировать в организме. По нашим данным хроническое течение иерсиниоза развивается у 16,6% пациентов и чаще наблюдается у лиц старше 25 лет. «Убежищем» возбудителей являются лимфатические узлы, тонкая кишка и клетки макрофагально-моноцитарного ряда. Активация очагов инфекции клинически может проявиться в виде уретрита, нефрита, энтерита, менингита и др. Из очагов антигены иерсиний выходят в кровь в составе иммунных комплексов, вызывая реактивные артриты, поражение почек, кишечника, органов зрения и др. Замедление скорости кровотока в тканях-мишенях создает благоприятные условия для депонирования антигенов Y. enterocolitica. Критерием персистенции возбудителя можно считать длительную (более 6 месяцев) циркуляцию специфического IgA к липополисахариду иерсинии.
Среди заболеваний, имеющих аутоиммунную природу и являющихся исходом иерсиниоза, преобладают серонегативная спондилоартропатия (чаще реактивные артриты и синдром Рейтера), ревматоидный артрит, аутоиммунный тиреоидит и болезнь Крона.
Лечение больных иерсиниозом и псевдотуберкулезом должно быть комплексным, патогенетически обоснованным и проводиться с учетом клинической формы и тяжести заболевания (
), (
). Важнейшей задачей является купирование симптомов острого периода и предупреждение неблагоприятных исходов болезни. Госпитализация больных иерсиниозом осуществляется по клиническим и эпидемиологическим показаниям. При легком и неосложненном среднетяжелом течении допускается лечение дома. По эпидпоказаниям госпитализируют больных, относящихся к декретированной группе (военнослужащие, работники водоканалов, пищеблоков и др.).
Для диетического питания используются столы № 4, 2 и 13. Антибактериальную терапию назначают на 10–14 дней (при гастроинтестинальной форме может быть ограничена семью днями) всем больным независимо от формы болезни в максимально ранние сроки (желательно до третьего дня болезни) [8].
Выбор препарата зависит от антибиотикочувствительности штаммов иерсиний, циркулирующих на данной территории (определяется два раза в год). В настоящее время предпочтение отдается фторхинолонам и цефалоспоринам третьего поколения [9, 10].
Основным направлением патогенетической терапии гастроинтестинальной формы иерсиниозной инфекции является пероральная (парентеральная) регидратация и дезинтоксикация полиионными растворами.
Тактика лечения больных абдоминальной формой согласуется с хирургом. Хирург решает вопрос о необходимости оперативного вмешательства. До операции и после нее в полном объеме проводится этиотропное и патогенетическое лечение.
При генерализованной форме этиотропные препараты, в большинстве случаев, назначаются парентерально. При генерализованных формах с явлениями пиелонефрита хорошо зарекомендовал себя пефлоксацин — 0,8 г/сутки. Левомицетина сукцинат используют при развитии менингита иерсиниозной этиологии (7–100 мг/кг в сутки). При тяжелом течении генерализованной формы проводят несколько курсов парентеральной антибиотикотерапии. Начинают с гентамицина — в течение 2–3 дней по 2,4–3,2 мг/кг в сутки, затем 0,8–1,2 мг/кг в сутки. При отсутствии терапевтического эффекта или непереносимости препаратов применяется стрептомицина сульфат в дозе 1 г/сутки. При развитии гепатита следует избегать назначения лекарств, обладающих гепатотропным действием. Больным с септической формой заболевания целесообразно в/в введение двух-трех антибиотиков разных групп (фторхинолоны, аминогликозиды, цефалоспорины). При неэффективности антибактериальной терапии Л. А. Галкина, Л. В. Феклисова (2000) рекомендуют использовать поливалентный иерсиниозный бактериофаг (50,0–60,0 мл 3 раза в день, № 5–7) в качестве моноэтиотерапии или в сочетании с антибиотиками [11].
Кроме этиотропного лечения показана патогенетическая терапия (дезинтоксикационные, общеукрепляющие, десенсибилизирующие препараты, стимулирующие средства). В комплексной терапии обязательно должны использоваться средства для лечения дисбиотических нарушений.
Большинству больных с выраженными астеническими, вегетативными и невротическими проявлениями требуется прием ноотропных препаратов, транквилизаторов, бромидов, настоя пиона, настойки пустырника, отвара валерианового корня и др. Подбор терапии в таких случаях согласовывают с психоневрологом и вегетологом.
Лечение больных с вторично-очаговой формой иерсиниоза проводится по индивидуальной для каждого больного схеме. Антибактериальные препараты не имеют самостоятельного значения, однако должны назначаться при появлении клинико-лабораторных признаков активизации инфекционного процесса и отсутствии в анамнезе сведений о приеме антибиотиков. Лечение пациентов согласовывается с ревматологом, гастроэнтерологом, эндокринологом, психоневрологом и др. специалистами (по показаниям). Иммунокорректоры должны назначаться больным строго по показаниям при отсутствии лабораторных признаков аутоиммунного процесса по результатам исследования иммунного статуса и аутоантител в крови больного.
Диспансерное наблюдение реконвалесцентов. До сих пор нет единого мнения о длительности и тактике диспансерного наблюдения реконвалесцентов иерсиниоза и псевдотуберкулеза. В соответствии с приказами и руководящими документами Минздрава (Приказ № 408 от 1989 г.; Приложение 6 к Приказу Минздрава РФ от 17.09.1993 № 220 «Положение о кабинете (отделении) инфекционных заболеваний» и др.) наблюдение за реконвалесцентами иерсиниозной инфекции проводится в зависимости от нозологии и тяжести болезни в течение 1–6 месяцев после выписки из стационара (при легких формах — один месяц, при среднетяжелых — три месяца, при тяжелых — шесть месяцев).
Некоторые исследователи для прогноза неблагоприятных исходов иерсиниоза рекомендуют использовать следующие показатели: неблагоприятный преморбидный фон (хронические заболевания, дисбактериоз 3–4 ст., отягощенный аллергологический анамнез и др.), длительно сохраняющееся снижение альбумина, альфа-протеинов, мочевиноаммиачного коэффициента, диспротеинемия, повышение концентрации аммиака крови, фибриногена, нейтрофилез, моноцитоз, лимфоцитоз, эозинофилия, низкая активность системы комплемента, снижение показателей Т- и В-лимфоцитов в периоде реконвалесценции и факторов неспецифической резистентности, высокие показатели циркулирующих иммунных комплексов (ЦИК), наличие HLA B7, B18 и B27, О (I) группа крови.
Однако динамическое наблюдение за больными, перенесшими иерсиниоз, и использование современных методов статистической обработки клинических и лабораторных параметров позволяют нам высказать мнение, что клинические проявления иерсиниоза и псевдотуберкулеза, их выраженность и длительность не являются объективными критериями прогноза, а значит, не могут быть использованы для прогноза течения и исходов болезни. Созданный нами алгоритм иммунопрогностического обследования (
) больных в острый период болезни и разработанная совокупность критериев оценки иммунограмм при иерсиниозе дают возможность врачам прогнозировать неблагоприятное течение и исход уже в первые 2–4 недели от начала болезни [12, 13].
По нашему мнению при отсутствии у больного критериев неблагоприятных исходов иерсиниоза инфекции рекомендуется диспансерное наблюдение за реконвалесцентами в течение одного года после выписки из стационара. При наличии показателей возможного формирования неблагоприятных исходов иерсиниоза диспансерное наблюдение должно проводиться в течение пяти лет после выписки из стационара — первый год каждые 2–3 месяца, затем один раз в шесть месяцев при отсутствии жалоб и отклонений в состоянии здоровья. При наличии клинико-лабораторного неблагополучия — более часто, по мере необходимости. По показаниям больные должны проходить клинико-лабораторное и инструментальное обследование у ревматолога, эндокринолога, кардиолога, окулиста, дерматолога и др.
Тактика диспансеризации больных иерсиниозами вообще не регламентирована приказами Минздрава РФ. Основываясь на собственных результатах длительного наблюдения больных иерсиниозом, мы рекомендуем следующую тактику их диспансеризации. После выписки из стационара продолжительность диспансерного наблюдения за перенесшими иерсиниоз, псевдотуберкулез при отсутствии генетических и иммунологических прогностических критериев неблагоприятных исходов должна составлять один год, при их наличии — не менее трех лет. Для контроля полноты выздоровления рекомендуется использовать следующую схему: в течение первого года после острого периода пациентов необходимо обследовать комплексно (клиническими, лабораторными, иммунологическими методами) каждые 2–3 месяца, затем один раз в шесть месяцев при отсутствии жалоб и отклонений в состоянии здоровья. При наличии клинико-лабораторного неблагополучия — более часто, по мере необходимости. По показаниям во время диспансеризации пациентов необходимо консультировать у других специалистов (ревматолога, гастроэнтеролога, эндокринолога, кардиолога, окулиста, дерматолога, гинеколога и гинеколога-эндокринолога) с проведением необходимых лабораторно-инструментальных исследований.
Литература
- Шестакова И. В., Ющук Н. Д., Андреев И. В., Шепелева Г. К., Попова Т. И. К вопросу о формировании иммунопатологии у больных иерсиниозом // Тер. архив. 2005; 11: 7–10.
- Опочинский Э. Ф., Мохов Ю. В., Лукина З. А., Ясинский А. А. Анализ деятельности центров ГосСанЭпиднадзора РФ по лабораторной диагностике иерсиниозов. В кн.: Инфекции, обусловленные иерсиниями (иерсиниоз, псевдотуберкулез), и другие актуальные инфекции. СПб, 2000: 42–43.
- Филатов Н. Н., Салова Н. Я., Голованова В. П., Шестеперова Т. И. Современное состояние лабораторной диагностики иерсиниозов в Москве. В кн.: Инфекции, обусловленные иерсиниями (иерсиниоз, псевдотуберкулез), и другие актуальные инфекции. СПб, 2000: 59–60.
- Шестакова И. В., Ющук Н. Д., Попова Т. И. Иерсиниоз: диагностические ошибки // Врач. 2007; № 7: 71–74.
- Ющук Н. Д., Шестакова И. В. Проблемы лабораторной диагностики иерсиниозов и пути их решения // ЖМЭИ. 2007; № 3: 61–66.
- Гукасян Г. Б., Хачатрян Т. С., Алексанян Ю. Т., Ханджян Г. Ж. Эпидемиологические закономерности иерсиниозов в Армении. В кн.: Инфекции, обусловленные иерсиниями (иерсиниоз, псевдотуберкулез), и другие актуальные инфекции. СПб, 2000: 13.
- Белая Ю. А. Иерсинии у «здоровых» людей. Результаты многолетних проспективных исследований. В кн.: Инфекции, обусловленные иерсиниями (иерсиниоз, псевдотуберкулез), и другие актуальные инфекции. СПб, 2000: 5.
- Кареткина Г. Н. Иерсиниозы. В кн.: Ющук Н. Д., Венгеров Ю. Я. (ред.) Лекции по инфекционным болезням. М.: ВУНМЦ; 1999: 339–354.
- Лучшев В. И., Андреевская С. Г., Михайлова Л. М. и др. Лечение больных иерсиниозами препаратами фторхинолонового ряда // Эпидем. и инфекц. Болезни. 1997; 3: 41–44.
- Дмитровский А. М., Карабеков А. Ж., Меркер В. А. и др. Клинические аспекты иерсиниозов в Алматы. В кн.: Инфекции, обусловленные иерсиниями (иерсиниоз, псевдотуберкулез), и другие актуальные инфекции. СПб, 2000: 17–18.
- Галкина Л. А., Феклисова Л. В. Результаты применения поливалентного иерсиниозного бактериофага в лечении иерсиниоза у детей. В кн.: Инфекции, обусловленные иерсиниями (иерсиниоз, псевдотуберкулез), и другие актуальные инфекции. СПб, 2000: 11.
- Шестакова И. В., Ющук Н. Д., Балмасова И. П. Клинико-прогностические критерии различных форм и вариантов течения иерсиниозной инфекции // Тер. архив. 2009, т. 81,11: 24–32.
- Шестакова И. В., Ющук Н. Д. Хронический иерсиниоз как терапевтическая проблема // Тер. архив. 2010, т. 82, 3: 71–77.
И. В. Шестакова, доктор медицинских наук, доцент Н. Д. Ющук, доктор медицинских наук, профессор, академик РАМН МГМСУ, Москва
Контактная информация об авторах для переписки
Купить номер с этой статьей в pdf
Что необходимо для постановки диагноза?
При появлении первых признаков недуга пациенту следует обратиться к гастроэнтерологу и инфекционисту. В случае возникновения осложнений возможно потребуется консультация нефролога, невролога и кардиолога.
Для выявления кишечного иерсиниоза потребуется консультация инфекциониста
Диагностика иерсиниоза включает в себя проведение таких исследований:
- бактериологический посев мазка из носоглотки и мокроты;
- анализ крови;
- ЭКГ;
- анализ мочи, кала, спинномозговой жидкости, желчи;
- УЗИ органов брюшной полости;
- колоноскопия;
- КТ;
- иммунологические и серологические тесты;
- лапароскопия;
- рентгенография;
- сонография;
- ректороманоскопия.
Биологическим материалом для проведения микробиологической диагностики выступают:
- кал;
- урина;
- кровь;
- мокрота;
- смывы из зева;
- желчный секрет;
- спинномозговая жидкость;
- ткани, взятые при оперативных вмешательствах.
Также проводится бактериологический посев помещения, в котором находится больной. Исследовать также стоит овощи, фрукты, посуду, кухонные принадлежности. Бактериологический анализ имеет ряд недостатков. В первую очередь, это связано с низкой концентрацией инфекционных агентов в биоматериале, особенно в крови. Для получения максимально точного результата потребуется использование, как минимум четырех образцов.
Стоит также отметить, что данная диагностическая методика требует немало времени. Так один анализ может занимать от двух недель до месяца, а это затрудняет проведение лечебного процесса. По этим причинам специалисты часто пренебрегают бакпосевом или же назначают его в комплексе с другими исследованиями. Более достоверным анализом для постановки диагноза является выявление антител в крови больного.
В случае гастроинтестинального иерсиниоза в девяносто процентах случаев можно с точностью выявить или исключить наличие инфекционного агента. Проводить серологический анализ можно со второй недели после начала заболевания. Для достоверности диагноза, через две недели проводится повторное исследование. В исключительных случаях антитела к иерсиниям обнаруживаются в течение нескольких лет после выздоровления.
Для подтверждения диагноза берется кровь на выявление антител
Антибиотики при лечении кишечного иерсиниоза
Антибиотики при кишечном иерсиниозе помогают справиться с коварным возбудителем болезни. Назначаются антибиотики : аминогликозиды, цефалоспорины III-IV поколения, левомицетин и другие.
Врачи стараются назначать антибиотики ребенку через рот, но при тяжелых и генерализованных формах эти лекарства вводятся внутримышечно или внутривенно. Курс лечения антибиотиками зависит от степени тяжести инфекции, но обычно он продолжается 1-2 недели.
Возможные осложнения иерсиниоза
Иерсиниоз способен приводить к опасным осложнениям со стороны всех органов и систем:
- миокардит (воспаление сердечной мышцы);
- гепатит (воспаление печени);
- панкреатит (воспалительный процесс в поджелудочной железе);
- острый аппендицит (см. также: аппендицит у ребенка: как определить заболевание в домашних условиях?);
- непроходимость кишечника;
- менингит, поражение головного мозга (см. также: менингит у детей: инкубационный период заболевания).
Все эти осложнения очень опасны и несут угрозу не только здоровью, но и жизни малыша. Чем младше ребенок, тем тяжелее для него последствия иерсиниоза. В течение 5 лет после болезни она может еще давать о себе знать, поэтому нужно сразу обращаться к педиатру при плохом самочувствии, и вовремя проходить плановые осмотры.
При своевременном обнаружении и обращении к врачу иерсиниоз хорошо поддается лечению и не дает осложнений. В этом случае есть большие шансы на полное выздоровление.
Как можно заразиться?
Важным свойством иерсинии является способность выдерживать низкие температуры. Так она способна размножаться при температуре +4-+8 градусов, не погибает при повторном замораживании, способна длительно существовать в почве, воде, на различных пищевых продуктах, а в условиях низкой температуры и повышенной влажности хорошо размножается и накапливается. Более того, вызвать заболевание могут только штаммы, которые прошли этап размножения на продуктах, хранящихся в холодильнике.
Возбудитель заболевания быстро погибает при воздействии прямого солнечного света, высокой температуры, при кипячении погибает через 10-30 сек. Дезинфицирующие вещества (например, 3% раствор хлорамина) убивают микроб в течение 1-2 ч.
Иерсиния часто встречается в природе, она выделена из фекалий млекопитающих (особенно часто свиней, грызунов), птиц, рыб, земноводных, насекомых, обнаружена на овощах, в почве и воде.
Чаще всего заражение происходит через продукты. Как отмечалось выше бактерия очень хорошо чувствует себя в холодильнике. Заражение псевдотуберкулезом часто происходит через салаты из сырых овощей. Особенно опасна для заражения капуста.
Источником заражения кишечным иерсиниозом являются рогатый скот, больной человек и другие продукты, инфицированные иерсиниями (сырое молоко, мясо). Заболевания являются преимущественно единичными.
На что обратить внимание в анамнезе?
Обычно дети заражаются кишечным иерсиниозом через инфицированные продукты питания, реже водным и контактно-бытовым путем. Поэтому стоит обратить внимание на следующие моменты:
- Если ребенок посещает коллектив, есть ли другие заболевшие с подобными симптомами?
- Не кормили ли ребенка не так давно продуктами питания, которые могли быть инфицированы иерсиниями (квашеная капуста, сырые овощи, в особенности из погреба или хранилища, некипяченое домашнее молоко и др.)?
- Есть ли в доме грызуны, домашние животные и скот (особенно это касается сельской местности)?
Возможные осложнения и прогноз для жизни
Осложнения иерсиниоза многочисленны. Среди них наиболее вероятны:
- менингоэнцефалит;
- гломерулонефрит;
- перитонит и перфорация кишечника;
- спаечная болезнь кишечника;
- кишечная непроходимость;
- панкреатит и холецистит;
- гепатит;
- миокардит.
Особенностью иерсиниозной инфекции является также склонность к развитию рецидивов (вероятность до 55%) и медленное выздоровление (полная выздоровление может затянутся на 4-6 месяцев).
Опасность для жизни человека представляет только самая тяжелая – септическая – форма, так как вероятность летального исхода составляет 50%.
Рекомендуем почитать:
Симбиотики: понятие, список препаратов и продуктов
Осложнения бактериальной инфекции
Обычно симптомы иерсиниоза у ребенка ограничены областью органов желудочно-кишечного тракта. Случается, что инфекция приобретает хронический характер, провоцирует изменения в различных органах тела. Как правило, в группу риска входят маленькие дети, пациенты с ослабленным иммунитетом, пожилые люди.
Осложнения иерсиниоза — воспаление сердечной мышцы, сепсис, менингит — чаще отмечаются у больных с наследственной предрасположенностью к аутоиммунным заболеваниям. Смертность при септической форме составляет от 20 до 50%.
Еще наблюдается такое осложнение, как реактивный артрит. Индуцирует поражение суставов бактерия иерсиния. Повышается температура, появляются местное покраснение и отек в области воспаленных коленных и голеностопных суставов. Возникает боль, нарушается двигательная активность. Если после заражения и острого периода появляются красные болезненные папулы на коже, то врачи ставят диагноз узловатая эритема. Происходит воспаление подкожной жировой клетчатки на голенях и предплечьях.
Когда необходимо обратиться к врачу
При появлении признаков иерсиниоза пациентам рекомендуется обратиться к педиатру или терапевту, который при необходимости назначит консультацию инфекциониста. Легкую форму патологии врачи разрешают лечить дома. В тяжелой ситуации потребуется дополнительно консультация хирурга, ревматолога и гепатолога.
К врачу следует обращаться с сильными болями в животе и длительной диареей, сопровождающейся повышенной температурой тела. Ранняя диагностика иерсиниоза и его адекватное лечение позволит ускорить выздоровление и предупредить осложнения. Соблюдение клинических рекомендаций исключит затяжную терапию.
Что такое иерсиниоз
Болезнь, возбудителем которой являются патогенные микроорганизмы рода иерсиний, называется иерсиниозом. Патологические процессы распространяются на многие внутренние органы, но первые симптомы появляются при поражении кишечника. От инфекционной болезни страдают не только взрослые, но и дети, особенно в дошкольном возрасте.
Иерсиниоз (клинические рекомендации врача важно соблюдать, чтобы предупредить серьезные осложнения) провоцирует энтеробактерия Yersinia Enterocolitica – грамотрицательная палочка. Развивается при низких температурах (холодильник, погреб, овощехранилище), а кипячение и дезинфицирующие вещества способствуют ее гибели.
Чаще возбудитель поражает тонкий кишечник, провоцируя энтероколит или гастроэнтероколит. В тяжелой ситуации развивается язвенная болезнь, патологические процессы затрагивают мезентериальные лимфатические узлы. Возбудитель, попадая в кровь, провоцирует бактериемию, на фоне чего воспалительный процесс поражает рядом расположенные с очагом внутренние органы.
Возбудители
Возбудитель болезни морфологически похож на возбудителя псевдотуберкулеза и чумы. Инфекция характеризуется острым течением, токсико-аллергической реакцией и мультиочаговостью.
Признаки болезни и наличие патогенной микрофлоры в организме инфекционисты выявляют следующими способами:
- грамотрицательная капсула, которая при окрашивании меняет цвет на розовый. Это говорит о наличии палочки;
- жгутики, обуславливающие быстрое распространение после попадания в организм;
- адгезин, который вместе с коллагеном провоцирует развитие артрита;
- продуцирование сериновой протеазы, разрушительно действует на защитный механизм слизистых и минимизирует эффективность защитного барьера перед проникновением патогенных организмов;
- способность кишечного иерсиниоза проникать сквозь слизистую оболочку кишечной стенки.
Диагностика
Так как иерсиниоз имеет различную симптоматику, схожую с другими заболеваниями, то для дифференциации проводится такая диагностика, как:
- общий анализ крови;
- биохимия крови;
- иммунологический анализ;
- бактериальный посев является самым информативным методом, но это достаточно долгий анализ. Для его проведения используют такой биоматериал, как: кал, моча, мокрота, смыв с задней стенки глотки;
- инструментальные методы: рентген, ЭКГ, УЗИ брюшной полости, КТ, лапароскопия.
Методы лечения иерсиниоза
Для борьбы с иерсиниозом используются медицинские препараты и народные средства (настои, отвары). Лечение должно быть комплексным и осуществляться под присмотром врача.
Лекарственные препараты
Во время терапии больному рекомендуется соблюдать постельный режим, пока не пройдут симптомы интоксикации. Легкую форму можно лечить в домашних условиях, строго соблюдая назначения врача.
Пациентов с иерсиниозом тяжелой степени госпитализируют. Учитывая форму и тип заболевания, лечением занимается гастроэнтеролог, инфекционист, иммунолог или семейный врач.
Больным назначают комплекс препаратов:
| Название группы | Наименование препаратов | Описание, курс, эффективность |
| Антибактериальные средства | «Левомицетин сукцинат растворимый», «Гентамицин», «Метациклин». | |
| Иммуномодуляторы | «Пентоксил», поливитамины, аскорбиновая кислота в больших дозировках. | |
| Кишечные сорбенты | раствор Рингера или глюкозы (10%). | |
| Антигистаминные средства | «Супрастин», «Тавегил». | |
| Кортикостероиды | «Преднизолон». |
Иерсиниоз (клинические рекомендации важно строго соблюдать, чтобы ускорить выздоровление и предупредить осложнения) лечат инфузионной терапией, она восстанавливает водный баланс. Сильная интоксикация, частая рвота, редкое мочеиспускание и нарушения в работе сердечно-сосудистой системы ухудшают состояние человека.
Народные методы
Нетрадиционная медицина применяется в комплексном лечении, помогает уменьшить неприятные симптомы интоксикации и улучшить состояние пациента. Важно проводить терапию под строгим контролем врача.
| Рецепт | Лечение и эффективность |
| Майский мед (250 г) смешать с «Кагором» (350 г). Добавить 150 г сока, полученного из листьев алоэ. Важно, чтобы растению было от 3 до 5 лет. Перед срезом листьев его не рекомендуется поливать 3-5 д. Все компоненты хорошо смешать, оставить в холодном месте на 7 суток, периодически встряхивая. | Полученное лекарство принимают при иерсиниозе 3 р. в сутки перед едой за 30 мин по 1 ст.л. на протяжении 2 недель. |
| Смешать мед и корень девясила в одинаковых пропорциях (по 1 ст.л.). Добавить «Портвейна» или «Кагора» (0,7 л). Варить полученную смесь на среднем огне 10 мин. Остудить, хорошо процедить и принимать по указанной схеме. | Лекарство пьют по 50 мл после приема пищи 2-3 р. в сутки на протяжении 14 д. |
| Залить листья ежевики (2 ст.л.) и цветки календулы (1 ст.л.) горячей водой (1 л), оставить на 2 ч. | Принимают по 2/3 ст. 3 р. в сутки. Лекарство улучшает состояние пищеварительной системы при инфекционных заболеваниях и восстанавливает стул (устраняет поносы). |
Проверенным и эффективным средством является можжевельник. Он помогает быстрее восстановиться организму после болезни.
Врачи рекомендуют каждый день жевать свежие ягоды растения на голодный желудок. В первый день – 1 ягода, на второй день – 2. Постепенно увеличивая их количество до 12 шт. Затем разжевывать ягоды следует в обратном порядке, уменьшая каждый день на 1 шт. На лечение понадобится 24 дня.
Можжевельник улучшает общее самочувствие пациента, повышает тонус организма и укрепляет его защитные силы.
Прочие методы
В процессе лечения иерсиниоза важно правильно питаться, чтобы не нагружать желудочно-кишечный тракт. Больше пить чистой воды для выведения токсинов из организма. Рекомендуемый рацион предусматривает рис варенный, каши в жидком виде, сухарики, паровые котлеты из постного мяса.
Некрепкий зеленый чай поможет уменьшить тошноту. Компот из сухофруктов содержит минеральные вещества, необходимые организму в период болезни. При желании съесть соленое блюдо, врачи рекомендуют пить кипяченую воду с добавлением поваренной соли в небольшом количестве.
Профилактика заболевания
Важно правильно обрабатывать и хранить продукты питания, кипятить воду для питья, избавляться от грызунов — переносчиков инфекции. Дератизацию в детских садах, школах, столовых, детских оздоровительных лагерях обычно проводят санитарно-эпидемиологические службы. Владельцам коттеджей и сельских домов следует самим позаботиться об уничтожении крыс и мышей.
Меры защиты семьи от инфекции — рекомендации:
- мойте проточной водой плодово-овощную продукцию перед закладкой в холодильник;
- употребляемые в пищу свежие ягоды и плоды не только ополаскивайте водой, но и обдавайте кипятком (либо счищайте кожицу);
- свежую капусту очистите от трех верхних листьев, затем промойте под краном;
- замороженные плоды также мойте перед приготовлением;
- ополаскивайте и вытирайте разделочную доску после нарезки продуктов;
- дезинфицируйте полки и стенки холодильника.
Профилактические прививки для защиты от заражения иерсинией не делают. Дети и взрослые должны соблюдать правила личной гигиены, не нарушать требования санитарии.
Лечение других заболеваний на букву — и
| Лечение илеуса |
| Лечение импетиго |
| Лечение интернет-зависимости |
| Лечение интерстициального нефрита |
| Лечение интраабдоминальных абсцессов |
| Лечение инфаркта |
| Лечение инфаркта легкого |
| Лечение инфаркта селезенки |
| Лечение инфекционной эритемы |
| Лечение истерии |
| Лечение ихтиоза |
| Лечение ишемического инсульта |
Информация предназначена исключительно для образовательных целей. Не занимайтесь самолечением; по всем вопросам, касающимся определения заболевания и способов его лечения, обращайтесь к врачу. EUROLAB не несет ответственности за последствия, вызванные использованием размещенной на портале информации.
Какими препаратами лечить иерсиниоз?
- Ципрофлоксацин — по 0,5 г 2 раза в сутки внутрь или 0,4 г 2 раза в сутки парентерально продолжительностью от 7 дней до 1 месяца в зависимости от клинического течения.
- Пефлоксацин — при наличии менингита по 0,4 г 2 раза в сутки парентерально.
- Тримоксазол — при несептическом течении иерсиниоза по 0,8 г сульфаметоксазол (действующего веещства) 2 раза в сутки в течение 3-7 суток.
- Цефтриаксон — при генерализированном течении в дозе 1,0 г 2 раза в сутки парентерально; продолжительность введения препарата зависит от клинической ситуации.
Пути заражения иерсиниоза
Подвержены поражению иерсиниями лица со слабыми защитными резервами, хроническими патологиями. Наблюдаются также и эпидемические вспышки, которые связаны с потреблением грязных овощей.
Причины появления кишечного заболевания
Такие инфекции, как иерсиниоз впервые были обнаружены в 1939 г. (США). В нашей стране Y. enterocolitica выделена М. А. Беловой и Г.В.Ющенко в 1968 г., позже описаны случаи заболеваний. Первые вспышки в Европе, зарегистрированы в 1962-1963 гг.
Этиология
Возбудитель заболевания Yersinia enterocolitica относится к семейству Enterobacteriaceae, роду Yersinia. Это грамотрицательные палочки с закругленными концами длиной 1,8 — 2,7 мкм, шириной 0,7-0,9 мкм. Спор и капсул не образуют. Обладают перитрихиальными жгутиками. В отличие от Y. pseudotuberculosis, в мазках из бульонных культур цепочек не образуют. Окрашиваются всеми анилиновыми красителями. Кишечные иерсиний — факультативные аэробы. Оптимальная для роста рН среды 7,2 — 7,4, температура +22 — 25° С. Подвижны при +20 — 22° С. Подвижность более выражена, чем у Y. pseudotuberculosis. Растут как на обычных, так и обедненных питательных средах. По биохимическим свойствам различают 5 биоваров Y. enterocolitica. У человека чаще обнаруживают III и IV биовары, реже — II.
Y. enterocolitica имеют соматический термостабильный (О), жгутиковый термолабильный (Н) антигены и антигены вирулентности в наружной мембране. По О-антигену различают 51 серовар Y. enterocolitica. Большинство штаммов, выделенных от людей, животных и из внешней среды, принадлежат к серовару 03, часть — 05, 027, 07, 08 и 09; единичные — другим 17 сероварам.
Все штаммы Y. enterocolitica имеют поверхностный антиген энтеробактерий, общий с рядом представителей семейства Enterobacteriaceae. Штаммы серовара 09 имеют антигенное родство с бруцеллами.
Энтеротоксигенность кишечного иерсиниоза
Заболевание связано с продукцией большого количества термостабильного энтеротоксина. Инвазивность и способность к внутриклеточному размножению особенно выражены у следующих сероваров Y.enterocolitica: 03, 05,027,09. Заболевания могут также вызывать серовары 08, 07, 06, 030 и др. Патогенный потенциал иерсиний детерминируется плазмидами вирулентности с молекулярной массой 42-48 МД. Иерсиний длительно сохраняются во внешней среде, хорошо переносят низкие температуры, чувствительны к действию дезинфицирующих средств и физических факторов (солнечный свет, кипячение и др.)
Эпидемиология
Источник — человек и животные, больные и носители. Среди животных чаще болеют свиньи, коровы, овцы, козы. Кишечный иерсиниоз реже поражает собак и кошек.
Механизм передачи — фекально-оральный. Пути передачи: пищевой, водный, контактно-бытовой.
Восприимчивость: всеобщая.
Заболеваемость
: преобладают спорадические случаи. Возможны вспышки болезни в организованных детских коллективах, семьях, стационарах.
Возрастная структура
. Симптомы иерсиниоза появляются у ребят всех возрастных групп, но чаще 3-5 лет. У малышей первого года жизни заболевание регистрируется в единичных случаях.
Сезонность
: подъем заболеваемости отмечается в период весны (март — май).
Иммунитет типоспецифический.
Патогенез заболевания
Входные ворота: возбудитель проникает в макроорганизм энтеральным путем. Патологический процесс развивается в 2-х направлениях: местное воспаление в желудочно-кишечном тракте, а также воздействие микробов, токсинов и других продуктов жизнедеятельности иерсиний на различные органы и системы (при диссеминации возбудителя лимфогенным и гематогенным путями). Развивается синдром интоксикации с вовлечением ЦНС, вегетативной нервной и сердечно-сосудистой систем.
У большинства детей возникает поражение желудка и кишечника (гастрит, гастроэнтерит, энтероколит). Происходит адгезия иерсиний к кишечному эпителию, его колонизация при минимальной инвазии или ее отсутствии. Местный воспалительный процесс может быть различной выраженности — от катарально-десквамативного до язвенно-некротического. Выделяемый иерсиниями термостабильный энтеротоксин вызывает интенсивную энтеросорбцию жидкости в кишечнике и нарушение водно-электролитного баланса. Механизм его действия связан с активацией системы простагландинов и аденилатциклазы в эпителиальных клетках . Лечение кишечного иерсиниоза должно быть начато незамедлительно.
Инфекционный процесс распространяется на регионарные лимфатические узлы (особенно мезентериальные) — происходит их гиперплазия, возникают микроабсцессы. Возможны некрозы лимфатических узлов, прорыв брыжейки и развитие перитонита. В процесс может вовлекаться аппендикулярный отросток.
Некоторые серовары Y. enterocolitica (03, 09, 08 и др.), обладающие выраженными инвазивными свойствами, вызывают генерализованную инфекцию. Из первичных очагов иерсиний попадают в кровь, затем — в печень, селезенку, головной мозг, почки, поджелудочную железу, легкие, кости, где образуются множественные микроабсцессы.
В развитии патологического процесса участвуют иммунные комплексы, содержащие специфические антигены.
Если кишечный иерсиниоз протекает в тяжелой форме, то возникают глубокие нарушения в системе иммунитета: снижаются фагоцитарная активность нейтрофилов, общее количество лимфоцитов, популяции хелпер-индукторов и супрессор-цитотоксических клеток, В-лимфоцитов, отсутствуют пролиферативные процессы В-клеток.
Y. enterocolitica могут вызывать аутоиммунные процессы. Этому, в частности, способствует наличие антигена гистосов-местимости HLA В-27, сходного по строению с антигеном возбудителя. Возможно, с данным процессом связаны такие редкие проявления, как сыпь, артралгии, артриты, миалгии, узловатая эритема, а также развитие затяжных и хронических форм болезни.
Диагностика заболевания дифференциальным методом
Стоит отметить, что дифференциальный метод диагностики применяется преимущественно при кишечных заболеваниях. Дело в том, что симптоматика практически у всех инфекции схожа, поэтому точный диагноз сначала поставить достаточно трудно.
Изначально ребенка направляют в лабораторию для сдачи соответствующих анализов. После того как врач получил на руки их результаты и у него имеются все данные о проявляющихся симптомах, он уже может сделать вывод о каком заболевании идет речь. Иерсиниоз у детей выявляется методом исключения, а это и есть дифференциальный метод.
Профилактика иерсиниоза
Предупредить инфекционное заболевание можно, достаточно помнить полезные рекомендации специалистов:
- Нельзя покупать, употреблять и хранить испорченные продукты.
- Овощи и фрукты для салатов следует тщательно выбирать, мыть и очищать.
- Готовые блюда важно хранить отдельно от сырых продуктов.
- Перед употреблением некоторые овощи рекомендуется бланшировать (капусту разрезать на 2-4 части).
- Зелень и лук тщательно перебирать перед использованием, замачивать в чистой воде и хорошо промывать.
- Для хранения сырых продуктов использовать отдельные емкости, контейнеры, пакеты.
- Салаты заправляют непосредственно перед трапезой.
- Сырые и готовые продукты разделывают, используя для каждого отдельный кухонный инвентарь.
- Пить кипяченую и качественную воду (бутилированную или фасованную).
- Мясным продуктам животного происхождения необходима достаточная термическая обработка.
Длительное хранение овощей и фруктов требует подготовки специального помещения. Его освобождают от старых продуктов, обрабатывают специальными дезинфицирующими средствами. Просушивают все емкости, стеллажи.
Важно! Помещение для хранения продуктов должно быть тщательно защищено от проникновения птиц, грызунов и других вредителей, переносчиков инфекции.
Причины возникновения и классификация болезни
Основная причина заболевания детей иерсиниозом – несоблюдение правил гигиены и употребление сырых фермерских продуктов. Передается болезнетворная бактерия с немытыми овощами и фруктами, некипяченым фермерским молоком, сырым мясом.
Часто заражение происходит на фермах, где разводят свиней. Хотя подхватить эту кишечную инфекцию можно и в городе – в транспорте, в детских учреждениях, погладив бездомное животное.
ЧИТАЕМ ТАКЖЕ: как лечится бактериальная кишечная инфекция у детей?
Иерсиниоз у детей делится на:
- гастроинтестинальный, вызывающий гастроэнтерит, илеит (воспаление кишки) и острый аппендицит (см. также: особенности лечения гастроэнтерита у детей);
- генерализованный, выраженный в виде заражения крови, гепатита, менингита, пиелонефрита, воспаления легких;
- вторично-очаговый – вызывает артрит, миокардит, энтероколит, узловую эритему и синдром Рейтера;
- смешанный, имеющий признаки разных заболеваний вышеописанных форм.
Как лечить иерсиниоз?
Лечение иерсиниоза предполагает комплексную терапию с учетом клинической формы, тяжести и периода заболевания. Этиотропная терапия на современном этапе, согласно рекомендациям ВОЗ, предусматривает назначение взрослым фторхинолонов, среди которых предпочтение отдают ципрофлоксацину, длительность курса которого составляет от 7 дней до 1 месяца в зависимости от клинического течения.
При наличии менингита назначают пефлоксацин парентерально, он проникает через ГЭБ.
При несептическим течения иерсиниоза рекомендуют также сульфаметоксазол-триметоприм (тримоксазол) в течение 3-7 суток.
При генерализированном течении возможно применение пефалоспоринив 3-го поколения, среди которых предпочтение отдают цефтриаксону, продолжительность введения которого зависит от клинической ситуации. В отдельных случаях можно назначать гентамицин или доксициклин.
Важнейшим принципом антибиотикотерапии при генерализированных формах является непрерывность и продолжительность курса антибиотикотерапии (до 7-10-го дня нормальной температуры тела).
При септических формах заболевания целесообразно введение 2-3 антибиотиков различных групп парентерально.
Патогенетическая терапия включает применение дезинтоксикационных, десенсибилизирующих, витаминных, метаболических, антиоксидантных препаратов.
Лечение больных с вторично-очаговой формой иерсиниоза является сложным, его проводят по индивидуальной схеме. В случае рецидивирующего, затяжного течения иерсиниозного полиартрита, развития синдрома Рейтера, узловатой эритемы коротким курсом назначают глюкокортикостероиды.